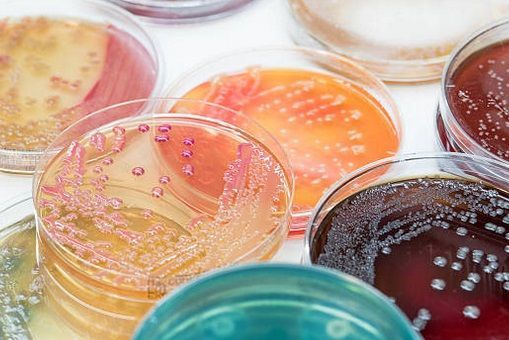

BLOG
🌿
L’histoire évolutive des algues marines : des origines à aujourd’hui
Les algues marines sont parmi les premiers organismes photosynthétiques à avoir colonisé les océans. Leur évolution a façonné les écosystèmes marins depuis plus de 1,5 milliard d’années, bien avant l’apparition des plantes terrestres. Comprendre leur histoire permet de mieux saisir leur importance écologique, alimentaire et biotechnologique actuelle.
🧬 Des origines microbiennes : les cyanobactéries, pionnières de la photosynthèse
Les premières traces de vie photosynthétique remontent à 3,5 milliards d’années, avec les cyanobactéries, parfois appelées « algues bleues », bien qu'elles ne soient pas de vraies algues. Ces micro-organismes ont joué un rôle essentiel dans la Grande Oxydation de l’atmosphère terrestre, en produisant de l’oxygène via la photosynthèse.
Elles forment aujourd’hui de véritables forêts marines et sont cruciales dans la régulation du carbone océanique (CNRS, 2023).
🌱 Algues vertes : des océans à la terre ferme
Les Chlorophytes (algues vertes) se sont diversifiées en milieu marin, puis en eau douce. Vers 500 millions d’années, certaines lignées — les Charophytes — ont développé des adaptations aux milieux secs : cuticule, stomates, reproduction sexuée complexe.
Elles sont à l’origine des plantes terrestres (Embryophytes), marquant l’une des étapes majeures de l’évolution de la vie.
🌍 Rôle écologique et fonctionnel des algues marines
Aujourd’hui, les algues marines représentent plus de 30 000 espèces estimées. Parmi elles, seules 27 espèces sont autorisées à la consommation humaine en France ( CEVA, 2023).
Elles jouent un rôle fondamental dans les écosystèmes marins : production d’oxygène, absorption du CO₂, abri et nourriture pour de nombreuses espèces, stabilisation des fonds marins, etc.
Cette étape est déterminante : elle a permis l’apparition d’organismes aérobies et préparé le terrain pour l’évolution des algues eucaryotes (INSB CNRS).
🔄 Endosymbiose : naissance des algues rouges et vertes
Il y a environ 1,5 milliard d’années, une cellule eucaryote a intégré une cyanobactérie photosynthétique : c’est l’endosymbiose primaire. De cette union sont nées deux grandes lignées d’algues :
- Les Rhodophyta (algues rouges), dépourvues de flagelles, riches en phycoérythrine.
- Les Chlorophyta (algues vertes), ancêtres directs des plantes terrestres.
Ces lignées ont colonisé les environnements marins et d’eau douce, ouvrant la voie à une immense diversité d’algues multicellulaires.
🟤 L’apparition des algues brunes : une évolution secondaire
Les algues brunes (Phaeophyceae) sont apparues plus tard, entre 300 et 450 millions d’années. Elles résultent d'une endosymbiose secondaire : une cellule eucaryote hétérotrophe a absorbé une algue rouge unicellulaire.
Cette origine explique leur spécificité :
- Pigments uniques (fucoxanthine, donnant leur couleur brune)
- Grande taille (ex. : laminaires, kelp)
- Organisation tissulaire complexe
🌊 De l’évolution à l’adaptation : comment les algues marines ont façonné les fonds océaniques modernes
🧬 Diversification morphologique des algues marines
Au cours de leur évolution, les algues marines ont développé une variété de structures morphologiques adaptées à leurs environnements :
- Thalles filamenteux : présents chez des algues comme Spirogyra, ces structures simples consistent en une seule file de cellules.
- Thalles tubulaires : observés chez Entomorpha, où les filaments s'associent pour former des tubes creux.
- Thalles foliacés : comme chez Ulva lactuca, où les filaments se juxtaposent pour former des lames repliées.
- Thalles à cladome : structures complexes avec des axes dressés et des ramifications latérales, observées chez des algues comme Sargasse.
Ces adaptations morphologiques ont permis aux algues de coloniser divers habitats marins, des zones intertidales aux profondeurs océaniques.
🌍 Rôle écologique des algues dans les écosystèmes marins
Les algues marines jouent un rôle crucial dans les écosystèmes océaniques :
- Production primaire : elles sont à la base de la chaîne alimentaire marine, produisant de l'oxygène et fixant le carbone.
- Habitat : les forêts de kelp, formées par des algues brunes comme Macrocystis pyrifera, offrent un habitat à une multitude d'espèces marines.
- Protection côtière : les structures denses des algues atténuent l'énergie des vagues, protégeant les côtes de l'érosion.
❄ Impact des glaciations et du réchauffement climatique
Les périodes glaciaires ont eu un impact significatif sur la distribution et l'évolution des algues :
- Refuges glaciaires : durant les glaciations, certaines algues ont survécu dans des refuges isolés, entraînant une diversification post-glaciaire.
- Réchauffement actuel : le réchauffement climatique favorise la prolifération d'algues glaciaires pigmentées, comme Ancylonema spp., qui réduisent l'albédo des glaces et accélèrent leur fonte.
🔬 Perspectives futures et recherche génomique
Des initiatives comme le programme "Atlasea", piloté par le CNRS et le CEA, visent à constituer une base de données des génomes de référence de 4 500 organismes marins eucaryotes des eaux françaises. Ces recherches permettront de mieux comprendre l'évolution des algues et leur adaptation aux changements environnementaux.

L’histoire de l’algue marine en Bretagne
L'histoire de l'algue marine en Bretagne remonte au Moyen Âge, voire même plus tôt. Les Bretons ont une relation complexe et profonde avec cette plante marine aux multiples vertus.
Dès le Moyen Âge, les populations côtières de Bretagne utilisaient les algues marines, notamment les goémoniers, pour fertiliser leurs terres. Le goémon, terme breton signifiant algue, était utilisé comme engrais naturel pour amender les sols et augmenter les rendements agricoles. Ce précieux amendement organique était récolté à marée basse et séché sur les côtes avant d'être répandu sur les champs. Cette pratique traditionnelle est encore présente aujourd'hui, bien que moins répandue.
Au fil des siècles, l'usage des algues marines en Bretagne a évolué. Progressivement, les algues ont été exploitées pour leurs propriétés alimentaires, industrielles et cosmétiques. En effet, les algues marines sont riches en minéraux, vitamines, oligo-éléments, fibres et protéines, ce qui en fait un aliment très nutritif. Les Bretons les consommaient principalement sous forme de soupe, de salade ou intégrées à des plats traditionnels.
Au cours du XIXe siècle, l'industrie de l'algue marine s'est développée en Bretagne. Les algues étaient récoltées en grande quantité pour êtretransformées en produits tels que l'iode, les alginates (utilisés dansl'industrie alimentaire et pharmaceutique), les cosmétiques et même le textile.Des entreprises spécialisées dans la récolte, le séchage et la transformation des algues ont vu le jour, contribuant ainsi à l'économie locale.
Cependant, au début du XXe siècle, l'industrie de l'algue a connu un déclin important en raison de l'arrivée des engrais chimiques et de la concurrence internationale les coûts élevés et la baisse de la demande ont entraîné la fermeture de nombreuses entreprises d'exploitation des algues marines.
Malgré cette période difficile, les algues marines ont retrouvé un nouvel essor grâce à leur utilisation en cosmétique et en cuisine. Les algues ont été redécouvertes comme une source de bienfaits pour la peau et les cheveux, et sont devenues des ingrédients populaires dans les produits de soin naturels. En cuisine, les chefs bretons ont intégré les algues à leurs recettes pour donner une touche d'originalité et de saveurs marines à leurs plats.
Aujourd'hui, la Bretagne possède un riche patrimoine d'algues marines. La région est connue pour ses algues de grande qualité et la diversité des espèces présentes sur ses côtes. Des associations de professionnels, des collectivités locales et des chercheurs travaillent ensemble pour préserver cette ressource naturelle et promouvoir son utilisation durable. Des festivals et des événements sont également organisés pour sensibiliser le grand public à la richesse des algues et à leur importance écologique.
L'histoire de l'algue marine en Bretagne est donc celle d'une plante ancestrale qui a su s'adapter aux besoins et aux évolutions de la société. De l'utilisation comme engrais à l'exploitation industrielle, en passant par son utilisation alimentaire et cosmétique, l'algue marine reste un symbole fort de la culture bretonne et de sa relation intime avec la mer.
c.Groos
🌿 Une alternative prometteuse aux protéines animales
Face aux défis environnementaux et aux besoins nutritionnels croissants, les algues marines émergent comme une solution durable et nutritive. Le programme PROMALG-Health, lancé en Bretagne, explore le potentiel des macroalgues pour diversifier nos sources de protéines.
🍃 Des algues riches en protéines
Certaines algues, comme la laitue de mer (Ulva sp.), la dulse (Palmaria palmata) et la gracilaria (Gracilaria sp.), présentent une teneur élevée en protéines. Par exemple, la dulse peut contenir jusqu'à 47 % de protéines sur matière sèche, avec un profil en acides aminés essentiels comparable à celui du soja, ce qui en fait une alternative intéressante pour les régimes végétariens et véganes .
🏥 Des applications concrètes en milieu hospitalier
Le CHU de Brest expérimente l'intégration de ces algues dans les repas de ses patients, notamment sous forme de quiches ou de cakes. Cette initiative vise à enrichir l'alimentation en protéines tout en réduisant la consommation de viande, répondant ainsi aux objectifs de santé publique et de durabilité .

Algues & thyroïde
mythe ou réel impact de l’iode ?
L'iode est un oligo élément indispensable a l’équilibre de notre métabolisme .
Les macro-algues marines sont des aliments riches en nutriments (vitamines, minéraux, oligoéléments, antioxydants …) , et en particulier en iode. Cet oligo-élément est essentiel au bon fonctionnement de la thyroïde, mais sa surconsommation peut avoir des effets inverses. Alors, consommer des algues est-il bénéfique ou risqué pour la thyroïde ? Voici ce que dit la science.
L’iode, indispensable au fonctionnement thyroïdien
L’iode est un composant fondamental des hormones thyroïdiennes (T3 et T4), qui régulent le métabolisme, la température corporelle, la croissance et le développement cérébral.
Apports journaliers recommandés (AJR) (source : OMS / ANSES) :
- Adultes : 150 µg/jour
- Femmes enceintes : 200–250 µg/jour
- Enfants (1-12 ans) : 90–120 µg/jour
- Limite supérieure de sécurité (EFSA) : 600 µg/jour pour les adultes
Note : Les teneurs en iode mentionnées (par exemple jusqu’à 341 000 µg/100 g) concernent les algues déshydratées, beaucoup plus concentrées que l algues fraîches qui contiennent environ 5 à 10 fois moins d’iode que les mêmes algues une fois séchées, car elles sont composées à plus de 80 % d’eau.
Donc : - 1 g d’algue fraîche contient en moyenne entre 50 et 200 µg, donc plus modéré que l'algue sechées.
Les teneurs en iode varient énormément selon le type d’algue (les plus riches en iode sont surtout les brunes ), sa zone de récolte, et surtout selon qu’elle est fraîche ou déshydratée. Les chiffres cités concernent les algues séchées, dont la concentration est plus élevée. Une consommation quotidienne se situe autour de 1 à 2 g d’algues séchées, ou 5 à 10 g d’algues fraîches, selon l'espèce.
Il est admis qu'il faut 8 a 10kg d'algues fraiches pour avoir 1 kg d'algues séchées.
Les macro-algues : une source naturelle d'iode, a gérer avec intelligence …
Ordres de grandeur (source : ANSES, EFSA) :
- Algue déshydratée : 500 à 2000 µg d’iode par gramme sec (voire plus selon l’espèce)
- Algue fraîche : 50 à 200 µg d’iode par gramme
Quels risques en cas d’excès d’iode ?
Un apport chronique ou brutalement élevé en iode peut perturber la fonction thyroïdienne, notamment chez les personnes sensibles (antécédents, maladies auto-immunes, personnes âgées ou malades).
Conséquences possibles :
- Hypothyroïdie induite par excès d’iode (effet Wolff–Chaikoff)
- Hyperthyroïdie chez les personnes à risque
L’ANSES recommande la prudence : « La consommation régulière d’algues riches en iode peut conduire à des apports excédant les seuils recommandés».il faut donc varier les algues que vous consommez.
Populations à surveiller
Une vigilance s’impose pour :
- Les personnes atteintes de troubles thyroïdiens (hypo/hyper)
- Les femmes enceintes/allaitantes
- Les enfants
- Toute personne sous traitement à base d’iode ou de lithium
Conseils :
- Il y a les algues à teneur modérée (laitue de mer par exemple )
- Éviter la consommation quotidienne d’algues très riches comme le kombu (vous pouvez alterner les algues consommées)
- Ne pas associer algues + compléments iodés sans avis médical
- Évitez de dépasser 1 à 2 g/jour d’algue déshydratée, sauf recommandation spécifique
et le conseil de la sagesse : alternez, variez, vos consommations quotidiennes d'algues
Conclusion
Oui, les macro-algues peuvent influencer la thyroïde : leur richesse en iode en fait à la fois un allié nutritionnel puissant, mais un aliment à manier avec intelligence. Pour la majorité des gens, une consommation raisonnable, variée et informée reste bénéfique.
Pour acheter des algues séchées (que vous pouvez conserver un an et plus ) :
https://www.lequotidienaunaturelshop.com/algues-seches
#algues #thyroïde #iode #iodealgues #santéthyroïdienne #alguesmarines #nutritionmarine #superaliments #carenceiode #excèsiode #alimentationvégétale #bienfaitsalgues #macroalgues #énergienaturelle #hormonesthyroïdiennes #naturopathie #oligoéléments #fatiguethyroïde

Prévention du cancer : quand la science rejoint la mer
Algues marines bretonnes & cancer : un potentiel naturel sous la loupe des scientifiques
Face à l’augmentation des cancers et à la recherche de solutions complémentaires naturelles, certaines algues marines comestibles attirent l’attention des chercheurs. Riches en composés bioactifs (antioxydants, polysaccharides, minéraux), les algues bretonnes — comme la laitue de mer, la dulse, le nori, le kombu royal, le wakamé et le haricot de mer — présentent des propriétés prometteuses pour la prévention et l’accompagnement de certains cancers.
🧪 Ce que montre la recherche scientifique
- 1. Laitue de mer (Ulva lactuca) : une alliée antioxydante
Une étude menée par l'Université de Bretagne Sud (2020) a démontré que les extraits d’Ulva lactuca possèdent des capacités antioxydantes importantes, capables de réduire le stress oxydatif, un facteur favorisant le développement tumoral. (Source : UB Sud, revue Antioxidants)
- 2. Kombu royal (Laminaria digitata) & Wakamé : le rôle des fucoïdanes
Ces algues brunes sont riches en fucoïdanes, des polysaccharides étudiés pour leur capacité à :
- inhiber la prolifération cellulaire (essais in vitro sur cellules de cancer colorectal – Inserm Nantes, 2018)
- stimuler l’apoptose (mort programmée des cellules cancéreuses)
- renforcer l’immunité (modulation des macrophages et lymphocytes)
- 3. Dulse (Palmaria palmata) & Nori : pigments et peptides protecteurs
La dulse et le nori contiennent des pigments (phycoérythrine, chlorophylle a) et des peptides qui ont montré des effets antiprolifératifs dans plusieurs essais précliniques sur cellules tumorales du foie et du sein (INRAE Rennes, 2022).
- 4. Haricot de mer (Himanthalia elongata) : un espoir discret
Moins connue, cette algue brune contient des polyphénols marins aux propriétés anti-inflammatoires et anticarcinogènes potentielles, en cours d'étude dans des programmes européens sur les biomolécules alimentaires.
🧬 Prévention, pas miracle
Les scientifiques sont clairs : les algues ne remplacent pas les traitements médicaux, mais elles peuvent complémenter une alimentation protectrice. Leur richesse en fibres, iode, magnésium et antioxydants en fait des alliées du microbiote, de la détoxification cellulaire et de l'équilibre hormonal, autant de facteurs impliqués indirectement dans la prévention du cancer.
⚠ Ce qu’il faut retenir
- Sources sérieuses : les recherches évoquées sont issues de laboratoires français (UBS, INRAE, Inserm), de publications européennes (Marine Drugs, Food & Function).
- Pas d’effet miracle, mais des pistes solides, notamment pour l’alimentation préventive et le soutien de l’immunité.
- Les algues bretonnes bénéficient d’une traçabilité et d’un mode de récolte durable, gage de qualité et sécurité alimentaire

Vous avez dit Crudivore ?
L'alimentation vivante.
Le crudivorisme est une forme d'alimentation basée sur la consommation, uniquement, d'aliments crus : ainsi les aliments conservent mieux leurs nutriments et vitamines, et ainsi ne sont pas être altérés par la cuisson. Les crudivores consomment souvent des fruits, légumes, graines, germes,noix, amandes diverses, … adoptant souvent un régime exclusivement végétal.
Les Bienfaits de ce mode d’alimentation :
Le crudivorisme a plusieurs avantages pour la santé :
- Les aliments crus sont souvent plus riches en vitamines, minéraux et antioxydants.
- Les enzymes présents dans les aliments crus aident à la digestion.
- Un régime à base de fruits et légumes peut favoriser une alimentation moins calorique et plus riche en fibres.
Les Algues dans un régime crudivore :
Légumes de l’Océan, les Macro-algues Marines sont des super-aliments ; elles sont de plus en plus reconnues pour leurs bienfaits nutritionnels et leur utilisation croissante dans la cuisine.
Les macro-algues sont une source exceptionnelle de bienfaits pour l’organisme ;
Ce qu’elles contiennent :
- Vitamines et Minéraux : Riches en iode, calcium, fer, et différentes vitamines (A, B, C… et plus suivant les algues).
- Protéines : certaines algues, comme la dulse par exemple, en contiennent des quantités intéressantes.
- Oméga-3, acides Gras : un + important pour la santé cardiovasculaire.
- Fibres : Contribuent à la bonne digestion.
,
Utilisations dans votre alimentation :
Les algues peuvent être consommées de différentes manières :
- Salades : elles peuvent être incorporées crues dans des salades. Certaines personnes utilisent également les paillettes d’algues déshydratées, , comme des condiments dans leurs différentes préparations culinaires.
- Smoothies : elles peuvent être ajoutées à des smoothies pour un plus nutritionnel.
- Garnitures : Utilisées comme garniture pour les plats.,
- En tartare d’algues : très appréciés en entrée ou comme « amuses gueules », lors d’apéritifs.
- On peut les trouver dans des recettes telles que des sushis végétaux, des soupes froides, des pâtes à tartiner….
Précautions lors de l'intégration des algues marines, dans un régime crudivore :
- Les algues peuvent être consommées crues, cependant il faut absolument prendre la sécurité de choisir des aliments certifiés. (ceci afin d’éviter les pollutions des endroits non surveillés )
- Alternez la consommation des différentes espèces d'algues marines, afin de diversifier les nutriments et éviter la surconsommation d'iode. (Certaines algues, comme le kombu, en contiennent beaucoup.)
- Vous pouvez consommer également des algues fraiches produites et traitées « à la japonaise » (vous pouvez en trouver sur notre site, dans la boutique,en barquettes).
Le crudivorisme peut offrir des avantages certains pour la santé, surtout lorsque ce régime est enrichi d'aliments complets et nutritifs comme les macro-algues marines. Les crudivores peuvent profiter d'une alimentation encore plus bénéfique en intégrant des algues marines, dans leur alimentation.
C.Groos
Découvertes 2025
🧬 Découverte de 20 nouvelles espèces de laitue de mer : une avancée majeure pour la biodiversité marine et l'alimentation durable
Une équipe de biologistes de l'Université de Göteborg a récemment identifié 20 nouvelles espèces de laitue de mer (genre Ulva) dans les eaux froides de la mer Baltique et du Skagerrak. Cette découverte, fruit d'une analyse ADN approfondie sur plus de 10 000 km de côtes, révèle une diversité insoupçonnée de ces algues vertes [1] .
🌿 Une biodiversité marine sous-estimée
La laitue de mer, connue pour sa croissance rapide et sa richesse en nutriments, est largement étudiée pour ses applications en aquaculture et en alimentation. Cependant, cette étude démontre que ce groupe d'algues est bien plus diversifié qu'on ne le pensait, avec des espèces endémiques à la mer Baltique et d'autres potentiellement invasives [1] .
🍽 Vers de nouvelles opportunités alimentaires
applications alimentaires innovantes. Leur capacité à se reproduire facilement et à croître rapidement en fait des candidates idéales pour une production durable de super-aliments [1] .
🌍 Implications écologiques et économiques
Cette découverte souligne l'importance de la recherche en biodiversité marine pour la conservation des écosystèmes et le développement de solutions durables. Elle offre également des perspectives économiques pour les industries de l'aquaculture et de l'alimentation fonctionnelle [1] .
Source : 1. Earth.com: www.earth.com/news/biologists-discover-20-new-species-of-sea-lettuce
# Laitue de mer #Ulva #Macroalgues #Biodiversmarine #Alimentationdurable #Aquaculture #Super-aliments #Écologiemarine #Recherchescientifique #Algues comestibles
https://www.lequotidienaunaturelshop.com/boutique

🌿 Des algues marines pour produire desanticorps anticancer : une avancée majeure en biotechnologie
Une start-up normande, Alga Biologics, a récemment mis au point une méthode innovante pour produire des anticorps thérapeutiques à partir de microalgues marines. Cettenavancée pourrait révolutionner les traitements contre certains cancers, notamment le neuroblastome pédiatrique. [1]
🧬 Une technologie innovanteLes chercheurs utilisent la microalgue Phaeodactylum tricornutum comme "usine cellulaire" pour produire des protéines médicaments. Cette méthode permet de générer des anticorps capables de cibler les cellules cancéreuses et de stimuler le système immunitaire pour détruire les tumeurs.
🌱 Des avantages significatifs- Efficacité accrue : Les anticorps produits activent le système immunitaire trois fois plus efficacement que ceux issus de cellules de mammifères.
- Réduction des coûts : Le processus de production est jusqu'à 70 % moins coûteux que les méthodes traditionnelles.
- Impact environnemental réduit : La culture des microalgues nécessite moins d'énergie, car elle se fait à température ambiante.
🔬 Perspectives futures
Cette technologie offre des perspectives prometteuses pour le développement de traitements plus accessibles et durables contre le cancer. Elle illustre également le potentiel des algues marines dans le domaine de la biotechnologie médicale.
Source : France3 Régions:france3-regions.francetvinfo.fr/normandie/seine-maritime/rouen/des-algues-pour-guerir-le-cancer-l-innovation-d-une-start-up-normande-2964386.html

Macro algues marines : un espoir naturel contre
les maladies neurodégénératives ?
Les macro algues comestibles, bien connues pour leur richesse nutritionnelle, suscitent désormais l’intérêt des chercheurs pour leurs effets protecteurs sur le cerveau. Et si ces végétaux marins, consommés depuis des siècles, étaient aussi de futurs alliés contre Alzheimer ou Parkinson ?
Des composés neuro-protecteurs dans les algues
Les macro algues contiennent des substances bio actives rares : fucoïdanes, laminarines, polyphénols marins, phlorotannins ou encore pigments comme la fucoxanthine. Ces molécules présentent des effets :
- Antioxydants puissants : elles protègent les cellules nerveuses du stress oxydatif, un facteur clé dans les maladies neurodégénératives.
- Anti-inflammatoires : elles réduisent l’inflammation chronique du cerveau, impliquée dans la progression de maladies comme Alzheimer.
- Neuroprotecteurs : des études in vitro montrent que des extraits d’algues brunes peuvent ralentir l’agrégation de peptides bêta-amyloïdes (source : International Journal of Molecular Sciences, 2020).
Des recherches prometteuses mais à approfondir
Des travaux récents (Neurochemistry International, 2022) ont observé des effets positifs de la fucoxanthine sur la mémoire chez des modèles animaux. Une consommation régulière d’algues riches en iode, oméga-3 végétaux et antioxydants pourrait contribuer à une meilleure santé cérébrale sur le long terme.
Prévention douce, naturelle et accessible
Intégrer des algues alimentaires dans une alimentation végétale, variée et équilibrée pourrait donc, en prévention, soutenir la vitalité cognitive et ralentir le vieillissement neuronal. Les algues brunes comme le kombu, le wakame ou la laminaire digitée sont les plus étudiées dans ce domaine.

🌱 Les macroalgues marines : une solution naturelle pour
une agriculture durable
Une étude récente publiée dans Bioresources and Bioprocessing met en avant le potentiel des macroalgues marines comme source de biopesticides naturels. Riches en composés bioactifs tels que les terpènes, polyphénols et polysaccharides sulfatés, ces algues offrent des alternatives écologiques aux pesticides chimiques traditionnels.
🌿 Un atout pour l'agriculture biologique
Les biopesticides dérivés des macroalgues présentent plusieurs avantages :
- - Biodégradabilité : ils se décomposent naturellement sans laisser de résidus nocifs.
- - Faible toxicité : ils sont sans danger pour les organismes non ciblés, préservant ainsi la biodiversité.
- - Efficacité : certains composés ont démontré une action antifongique et antibactérienne significative.
Ces caractéristiques les rendent particulièrement adaptés à l'agriculture biologique et à la protection des cultures dans une optique de durabilité.
🔬 Référence scientifique
Advancing sustainable agriculture: the potential of seaweed-derived biopesticides from marine biomass, publié en mars 2025 dans Bioresources and Bioprocessing.
https://www.springeropen.com/search?query=Advancing+sustainable+agriculture%3A+the+potential+of+seaweed-derived+biopesticides+from+marine+biomass&searchType=publisherSearch
#Macroalgues #Biopesticides #AgricultureDurable #Écologie #InnovationAgricole #lequotidienaunaturelshop

L'algue Wakamé
Le wakamé, ou Undariapinnatifida, est une algue marine comestible originaire des eaux côtières de l'Asie de l'Est, notamment du Japon, de la Corée et de la Chine. Sa récolte et sa consommation remontent à plusieurs siècles, et elle occupe une place importante dans la cuisine japonaise, où elle est souvent utilisée dans des soupes, des salades et des plats mijotés.
Historique : Le wakamé a été traditionnellement cultivé et récolté par les bateaux de pêche dans les eaux froides des côtes asiatiques. Sa popularité s'est étendue au-delà de l'Asie au cours des dernières décennies, notamment grâce à la mondialisation des cuisines et à l'intérêt croissant pour la cuisine saine. Aujourd'hui, le wakamé est largement disponible dans le monde entier, souvent sous forme déshydratée, ce qui le rend facile à conserver et à préparer.
Qualités nutritionnelles : Le wakamé est reconnu pour sa richesse nutritive. C'est une excellente source de nutriments essentiels tels que les fibres, les vitamines (notamment la vitamine K, les vitamines du groupe B, et la vitamine C), ainsi que des minéraux comme le calcium, le magnésium, le fer et l'iode. En raison de sa faible teneur en calories, le wakamé est souvent intégré dans des régimes alimentaires divers.
De plus, le wakamé contient des composés bio actifs tels que des antioxydants et des polysaccharides, qui peuvent contribuer à des effets bénéfiques sur la santé, notamment en soutenant le système immunitaire et en aidant à réguler le métabolisme. Certaines études suggèrent également que le wakamé pourrait avoir des propriétés anti-inflammatoires et anticancéreuses.
Valeur culinaire : Le wakamé possède une texture délicate et une saveur douce qui peuvent rehausser divers plats. Traditionnellement, il est utilisé dans le célèbre miso shiru (soupe miso) et dans des salades comme le wakame salad, qui combine l'algue avec du concombre, du sésame et une vinaigrette légère. Il peut également être incorporé dans des sushis ou des rouleaux de printemps.
En résumé, le wakamé est bien plus qu'un simple ingrédient culinaire. Avec son histoire riche et ses multiples bienfaits pour la santé, il représente un choix alimentaire précieux et nutritif qui mérite d'être intégré dans nos régimes alimentaires modernes.


Source ; CEVA
Synthèse : https://www.ceva-algues.com/wp-content/uploads/2019/10/Synthese-reglementaire-2024.pdf
Votre cueillette d'algues marines en bord de mer
La cueillette des algues marines en bord de mer est une pratique ancienne qui consiste à ramasser des algues pour leur utilisation culinaire, médicinale ou cosmétique.
Il est recommandé de ne pas arracher les algues, mais de les couper délicatement pour favoriser leur régénération. Il est également crucial de ne pas prélever trop d'algues dans une même zone pour ne pas perturber l'équilibre naturel.
De plus, il est conseillé de consommer les algues cueillies avec prudence, en évitant celles provenant de zones polluées ou contaminées.
Il est recommandé de pratiquer la cueillette des algues marines de manière responsable et durable, en respectant l'environnement marin et en contribuant à sa préservation.
Quelques précautions
Les algues peuvent être récoltées en fonction de leur cycle de croissance et de la présence de la ressource donc lorsque la croissance des algues est plus importante. Il est important de respecter certaines réglementations pour préserver la biodiversité et garantir une exploitation durable des algues.
Les algues peuvent être récoltées dans différentes zones maritimes et côtières, en fonction des espèces d'algues recherchées.
En France, la récolte des algues est réglementée par la loi et doit se faire dans le respect de certaines règles, comme la taille minimale des algues récoltées, les zones de récolte autorisées et les quotas à respecter. Il est également essentiel de veiller à ne pas prélever de manière excessive les algues afin de ne pas compromettre l'équilibre écologique des écosystèmes marins. Il est également conseillé de respecter les bonnes pratiques de récolte afin de minimiser l'impact sur l'environnement, comme ne pas prélever plus que nécessaire, ne pas récolter d'espèces menacées ou protégées, et laisser les parties de l'algue encore attachées à leur support pour favoriser la repousse.
Il est recommandé de se renseigner auprès des autorités locales ou des organismes compétents pour connaître la réglementation spécifique à la récolte des algues dans une région donnée.
conservation de votre cueillette
Il existe plusieurs façons de conserver les algues, en fonction de leur type et de l'utilisation que l'on souhaite en faire. Voici quelques méthodes courantes de conservation des algues :
- Séchage : les algues peuvent être séchées à l'air libre ou dans un déshydrater alimentaire. Une fois séchées, elles peuvent être conservées dans un bocal hermétique à l'abri de la lumière. (Veillez a les déshydrater a moins de 40° afin de garder les qualités de la plante)
- Congélation : certaines algues peuvent être congelées pour les conserver plus longtemps. Il est recommandé de les blanchir avant de les congeler afin de préserver leur texture et leur saveur.
- Salage : les algues peuvent être conservées dans du sel pour les conserver plus longtemps. Il est important de les rincer avant de les utiliser pour enlever l'excès de sel.
- Conservation dans l'huile : certaines algues peuvent être conservées dans de l'huile d'olive ou une autre huile végétale pour en préserver la fraîcheur.
- Fermentation : certaines algues peuvent être fermentées pour les conserver plus longtemps et développer des saveurs uniques. Il est important de suivre une recette appropriée et de respecter des conditions d'hygiène strictes.
- Stérilisation : comme vous stériliseriez des conserves de haricots ; mettre les algues dans les bocaux, ajouter de l’ eau + sel + jus de citron, fermer et stériliser .
Il est essentiel de les conserver dans des contenants hermétiques pour éviter toute contamination.

Aperçu que quelques-unes des qualités nutritionnelles des algues marines.
La cuisine à base d'algues marines est une tradition très implantée en Extrême-Orient tandis que son introduction dans notre alimentation est plus récente.
En découvrant ces légumes marins, nous nous rendons compte non seulement de leurs saveurs, mais aussi de leurs vertus thérapeutiques exceptionnelles.
Les algues, accompagnent de délicieuses recettes, présentent un profil nutritionnel remarquable. Elles renferment des acides aminés essentiels, des minéraux rares mais facilement assimilables, des vitamines, des oligo-éléments et des fibres. Par contre, elles sont très faibles en matières grasses, ce qui les rend recommandées naturellement en cas de surpoids ou de taux de cholestérol élevé.
Les algues sont une source importante de minéraux (25% environ), de protéines complètes ayant tous les acides aminés essentiels (20%), de glucides principalement sous forme de fibres (53%), de lipides en très faibles quantités (de 2% à 5%) principalement composés d'acides gras polyinsaturés, et enfin, elles regorgent de nombreuses vitamines, notamment celles du groupe B, de la vitamine C et de la provitamine A.
L'algue Wakamé aux mille vertus ! Saviez-vous que cette fougère de mer renferme dix fois plus de calcium que le lait ? La laitue de mer est également deux fois plus riche en fer que le germe de blé.
Grâce à leur teneur élevée en fibres, les algues se révèlent être de véritables alliées diététiques. Leurs fibres insolubles accélèrent le transit intestinal, tandis que leurs fibres solubles gonflent au contact de l'eau dans l'estomac, limitant ainsi l'appétit.
Ces fibres créent également un gel qui protège les muqueuses de l'estomac et des intestins. Et cerise sur le gâteau, ce sont d'excellents réducteurs de cholestérol.
Mais les algues ne se limitent pas à leur valeur nutritionnelle exceptionnelle. Elles possèdent également des vertus ré équilibrantes pour votre santé.
La Wakamé, est une algue comestible très prisée dans la cuisine japonaise et coréenne. Avec ses 10 fois plus de calcium que le lait (1 300 mg/100 g contre 119 mg/100 g), elle offre donc une alternative précieuse .
La nori est une autre algue bien connue en France. Une fois séchée, elle devient un condiment traditionnel de la cuisine japonaise, utilisé dans de nombreux plats.Intégrez les algues à votre alimentation pour bénéficier de leurs multiples bienfaits.
L'algue Nori renferme une multitude de minéraux tels que le calcium, le magnésium et lelithium, en plus d'être riche en vitamines et en acides aminés. Elle est souvent recommandée dans les régimes végétariens en raison de sa teneur élevée en protéines (jusqu'à 47 % de sa matière sèche selon le CEVA), en vitamine A et même partiellement active en vitamine B12.
L'algue Kombu, quant à elle, joue un rôle alcalin en aidant à neutraliser les excès d'acidité dans l'organisme. Elle est également une source remarquable de sels minéraux tels que le fer, le calcium, le magnésium et l'iode, ce qui en fait un excellent reminéralisant et un hydratant efficace.
Sa valeur calorique est optimale, car elle est principalement constituée d'hydrates de carbone qui apportent une dose supplémentaire d'énergie.
De plus, l'algue Kombu est extrêmement riche en vitamines telles que la vitamine A, B1, B2, C, PP, B6 et B12, et facilite l'élimination du sodium tout en prévenant le durcissement des artères. Enfin, sa teneur en fibres contribue à réduire la constipation.

Potentiel des macro-algues : source
alimentaire alternative
Les algues marines, aussi connues sous le nom de macro algues, suscitent un intérêt croissant en tant que source alimentaire. Elles sont considérées comme une alternative durable et écologique à d'autres sources de protéines animales et végétales, et ont un potentiel énorme pour répondre aux besoins alimentaires de la population mondiale croissante.
Tout d'abord, les algues marines sont extrêmement riches en nutriments essentiels tels que les vitamines, les minéraux, les antioxydants et les acides gras oméga-3. Elles sont également une excellente source de fibres et de protéines végétales. Leur teneur élevée en vitamines, entre autres, la vitamine B12, en fait une option attrayante pour les personnes suivant un régime végétarien ou végétalien, qui peuvent souvent souffrir de carences nutritionnelles. De plus, les algues marines sont pauvres en calories et en matières grasses, ce qui en fait un choix sain pour ceux qui cherchent à maintenir un poids raisonnable.
Les avantages environnementaux : les algues marines sont cultivées dans l'eau de mer, et, ne nécessitent pas de terres agricoles . Par ailleurs, contrairement à l'élevage intensif, la culture d'algues marines ne nécessite pas d'utilisation excessive d'eau douce ni de l'utilisation de produits chimiques tels que les pesticides. De plus, les algues marines jouent un rôle essentiel dans la lutte contre le réchauffement climatique, car elles absorbent le dioxyde de carbone de l'atmosphère .
En utilisant les algues marines comme source alimentaire, nous contribuons à réduire notre empreinte carbone globale et à préserver les ressources naturelles.
Cependant, il existe des défis à relever dans l'utilisation des algues marines comme source alimentaire. L'un des principaux obstacles est la perception que certains consommateurs peuvent avoir à leur égard. Les algues marines sont souvent associées aux «algues nuisibles» qui peuvent causer des dommages environnementaux. Par conséquent, il est essentiel de sensibiliser et d'éduquer les consommateurs sur les avantages certains, des algues marines en tant que source alimentaire durable et sûre.
De plus, le manque d'infrastructures et de technologies de production adaptées constitue un autre défi. Les techniques de culture des algues marines doivent être développées pour assurer une production à grande échelle. Cela nécessite des investissements et une recherche approfondie pour améliorer les méthodes de culture, la récolte et le traitement des algues marines.
Il existe de nombreuses opportunités pour l'utilisation des algues marines comme source alimentaire alternative. De nombreuses entreprises ont déjà commencé à développer et à commercialiser des produits à base d'algues marines, tels que des snacks aux algues, des pâtes aux algues et même des substituts de viande à base d'algues. L'industrie de la restauration a également commencé à intégrer les algues marines dans leurs menus, offrant ainsi une alternative saine et respectueuse de l'environnement.
En résumé, les algues marines possèdent un potentiel énorme en tant que source alimentaire alternative. Leur contenu nutritionnel élevé, leur faible impact environnemental et leur potentiel de culture à grande échelle en font une option attrayante pour nourrir la population mondiale croissante de manière durable. Bien qu'il reste des défis à relever, les avantages et les opportunités de l'utilisation des algues marines sont nombreux. Il est donc essentiel de continuer à investir dans la recherche, le développement et l'éducation afin de promouvoir leur utilisation comme une solution alimentaire d'avenir.

L'algue marine, CHONDRUS

L'algue rouge, également connue sous le nom de Chondrus crispus, est une plante marine originaire du littoral de l'océan Atlantique Nord. Son nom provient de sa texture cartilagineuse et de ses ramifications frisées. On la retrouve également au large de l'Amérique du Nord et sur les côtes Est du Canada et des États-Unis. L'algue rouge est également connue sous les noms de "mousse d'Irlande", "goémon blanc" et "carragheen".
Autrefois, pendant les périodes de pénurie alimentaire, cette algue était fréquemment utilisée dans la cuisine française. Aujourd'hui, elle est principalement utilisée dans l'industrie alimentaire pour produire un agent épaississant, gélifiant et stabilisateur appelé carraghénane.
La mousse d'Irlande fait partie de la famille des gigartinacées. Elle présente une morphologie polymorphe et peut mesurer jusqu'à 7 à 15 cm de long. Sa couleur varie du rouge au vert en passant par le pourpre et le brun. Ses ramifications sont transparentes par endroits. Cette algue possède une base discoïde et une texture cartilagineuse.
En phytothérapie, la carragheen est utilisée depuis des siècles dans la médecine traditionnelle. Elle est notamment utilisée pour traiter les affections respiratoires telles que les bronchites, les pneumonies, les rhumes et la toux. Elle est également utilisée pour traiter les affections digestives, les insuffisances glandulaires, les déficiences organiques, l'obésité et d'autres problèmes de santé.
En plus de ses propriétés médicinales, l'algue rouge est également très appréciée en cosmétologie. Elle est riche en nutriments, en minéraux et en antioxydants, ce qui en fait un ingrédient idéal pour les soins de la peau et des cheveux. Elle est utilisée pour gélifier et épaissir les produits cosmétiques, et peut même être utilisée comme alternative naturelle au silicone.
Pour la peau, l'algue rouge est utilisée pour traiter divers problèmes cutanés tels que le psoriasis, la dermatose, l'eczéma et les coups de soleil légers. Elle possède des propriétés antivirales, antibactériennes, antimicrobiennes, hydratantes, nourrissantes, adoucissantes et assouplissantes. Ses antioxydants aident à lutter contre les rides et les radicaux libres responsables du vieillissement cellulaire. Elle convient à tous les types de peau, qu'elle soit normale, mixte, grasse ou sèche.
Pour les cheveux, l'algue rouge est hydratante, adoucissante et améliore la brillance des cheveux. Elle renforce les cheveux et favorise la pousse, tout en prévenant leur chute. Elle est également efficace contre les affections du cuir chevelu telles que les pellicules et l'eczéma.
L'algue rouge renferme de nombreux principes actifs bénéfiques pour la peau et les cheveux. Elle contient des acides gras polyinsaturés (oméga 3 et oméga 6), des phénols, des carraghénanes, de l'iode, du soufre, du calcium, du magnésium, du bêta-carotène, des vitamines (B et C), du zinc, du sélénium et du manganèse. Tous ces éléments contribuent à renforcer la barrière cutanée, maintenir l'hydratation, lutter contre les problèmes cutanés, favoriser la cicatrisation, stimuler la pousse des cheveux, protéger contre le vieillissement cellulaire et bien d'autres bienfaits.
De plus, l'algue rouge peut être utilisée comme un atout minceur. Elle a été démontrée pour réguler l'appétit, augmenter la sensation de satiété, réduire l'absorption des graisses alimentaires, favoriser le déstockage des graisses et brûler les graisses.
Cependant, il est important de noter que la consommation excessive d'algue rouge peut être toxique en raison de sa forte teneur en iode. Il est donc recommandé de limiter sa consommation à 10 grammes par jour (soit 2 cuillères à soupe).
En conclusion, l'algue rouge est une plante marine aux multiples bienfaits pour la santé, la beauté et la minceur. Elle est utilisée depuis des siècles en phytothérapie et en cosmétologie, et continue d'être appréciée pour ses propriétés médicinales, cosmétiques et minceur.
C.Groos
Vous pouvez en trouver sur notre boutique https://www.lequotidienaunaturelshop.com/boutique/Chondrus-deshydrate-moins-d1mm-France-15-KG-p620368288
Propriétés antimicrobiennes des composés
extraits d'algues marine
Les algues marines sont des trésors de la nature, regorgeant de nombreuses propriétés bénéfiques pour la santé. En plus de leur richesse en nutriments essentiels, Elles possèdent également des propriétés antimicrobiennes puissantes, qui en font des alliées de choix dans la lutte contre les infections bactériennes et fongiques.
Plusieurs études scientifiques ont démontré l'efficacité des composés extraits d'algues marines dans la lutte contre les micro-organismes pathogènes. En effet, elles contiennent une grande variété de molécules bioactives telles que les polyphénols, les polysaccharides et les peptides antimicrobiens qui possèdent des activités antibactériennes, antivirales et antifongiques.
Par exemple, des chercheurs ont découvert que les polyphénols extraits d'algues brunes comme le fucus ou le varech possèdent des propriétés antimicrobiennes significatives contre des bactéries pathogènes telles que Staphylococcus aureus, Escherichia coli et Pseudomonas aeruginosa (qui dans certains cas, ont développé des résistances,aux traitements traditionnels). Ces composés ont également montré une activité antifongique contre des champignons tels que Candida albicans.
De plus, les polysaccharides extraits d'algues rouges comme la dulse ou l'algue nori ont également démontré des propriétés antimicrobiennes prometteuses. Ces polysaccharides agissent en renforçant le système immunitaire et en inhibant la croissance des micro-organismes pathogènes.
Grâce à ces propriétés antimicrobiennes, les composés extraits d'algues marines sont de plus en plus utilisés dans divers domaines, tels que la cosmétique,l'agroalimentaire, la pharmacie et la médecine. Par exemple, on retrouve des extraits d'algues marines dans des crèmes et des lotions pour la peau, des compléments alimentaires, des produits de nettoyage et des médicaments.
En résumé, les composés extraits d'algues marines constituent une source précieuse d'agents anti microbiens naturels. Leur utilisation dans divers domaines offre des perspectives prometteuses pour lutter contre les infections causées par des micro-organismes pathogènes.
Par ailleurs les allergies aux algues sont très rares, nous pouvons les consommer sans inconvénient, et profiter de la multitude des bénéfices qu’elles apportent.
C.Groos


laminaria digitata
et Varech
L'algue en cosmétologie
Les algues marines sont de plus en plus populaires dans l'industrie de la cosmétique. Leur utilisation remonte à des millénaires, notamment dans les cultures asiatiques,où elles étaient considérées comme des trésors de beauté et de santé.Aujourd'hui, des études scientifiques ont confirmé les nombreux bénéfices de ces algues sur la peau, ouvrant la voie à de nouvelles perspectives pour les soins de beauté.
Les algues marines sont des organismes végétaux qui se développent dans les mers du monde. Elles se caractérisent par leur capacité à absorber et à concentrer une multitude de minéraux et de vitamines présents dans l'eau de mer. Cela en fait des sources naturelles riches en nutriments essentiels pour la peau.
La première propriété bénéfique des algues marines est leur pouvoir hydratant. En effet,ces plantes sont capables de retenir l'eau dans leurs cellules, ce qui permet à la peau de bénéficier d'une hydratation intense. De plus, les algues agissent comme un film protecteur sur la peau, limitant ainsi la perte d'hydratation et renforçant la barrière cutanée.
De nombreuses études ont également démontré leurs propriétés antioxydantes. Les antioxydants sont des composés qui aident à neutraliser les radicaux libres,responsables du vieillissement cutané. Les algues marines sont riches en antioxydants tels que les polyphénols, les caroténoïdes et les flavonoïdes, qui aident à protéger la peau contre les dommages liés aux radicaux libres et à prévenir l'apparition des rides et des ridules.
De plus, certaines algues marines sont reconnues pour leurs propriétés purifiantes et détoxifiantes. Elles aident à éliminer les impuretés et les toxines de la peau,ce qui contribue à la prévention des problèmes cutanés tels que les boutons et l'acné. Les algues marines sont également anti-inflammatoires, ce qui signifie qu'elles peuvent apaiser les irritations cutanées et aider à calmer les rougeurs et les démangeaisons.
Parmi les algues marines les plus connues dans l'industrie cosmétique, on trouve le fucus vesiculosus, également appelé varech, qui est couramment utilisé dans les produits anti-âges en raison de ses propriétés régénérantes et raffermissantes. Le laminaria digitata, quant à lui, est réputé pour ses vertus hydratantes et nourrissantes. Enfin, le spirulina platensis est une algue bleue-verte qui possède des propriétés éclaircissantes et revitalisantes.
Les bienfaits des algues marines sur la peau ont été validés par de nombreux essais cliniques et expérimentaux. Par exemple, une étude publiée dans le Journal of Cosmetic Dermatology a montré que l'application d'un extrait d'algues marines sur la peau pouvait améliorer l'élasticité cutanée et réduire les signes du vieillissement.
En synthèse, les algues marines sont de véritables joyaux de la nature pour la peau. Leurs propriétés hydratantes, antioxydantes, purifiantes et apaisantes en font des ingrédients prometteurs dans l'industrie de la cosmétique. Grâce à leurs nombreux nutriments et composés actifs, les algues marines offrent des possibilités infinies pour améliorer la qualité de la peau et lui redonner de l’éclat, naturellement.
Encore un domaine ou l’algue, révèle ses potentialités que je qualifie de «magiques» !
C.Groos
Pouvoirs stimulants dans les macro algues
Les algues sont connues depuis longtemps pour leurs nombreuses vertus nutritionnelles. Elles sont riches en minéraux, en vitamines et en antioxydants, ce qui en fait un excellent complément alimentaire. Mais de récentes études suggèrent que les algues pourraient également avoir des propriétés immunitaires, ce qui pourrait révolutionner le domaine de la santé.
Le projet Algolife, lancé en 2015, vise à étudier les effets des algues sur le système immunitaire et à les valoriser dans les domaines de la santé et de la nutrition. Le projet réunit trois industriels, chacun ayant des objectifs spécifiques. Olmix se concentre sur l'immunité et la protection microbienne des animaux, Diana Pet Food se penche sur la lutte contre le vieillissement et l'obésité des animaux de compagnie, et Triballat-Sojasun se spécialise dans l'alimentation humaine en utilisant la fraction protéique des algues.
Le projet bénéficie des vingt années de recherche menées par la Station biologique de Roscoff, qui a développé une panoplie d'enzymes marines capables de couper certains sucres des algues de manière précise. Ces enzymes permettent d'obtenir des extraits d'algues à haute valeur ajoutée, ce qui ouvre de nouvelles possibilités pour la valorisation des algues dans le domaine de la santé et de la nutrition.
Agrival, une filiale de la Sica de Saint-Pol-de-Léon, cultive actuellement ces enzymes dans des biofermenteurs. Une fois les extraits d'algues obtenus, ils sont testés sur des animaux. Des essais sont en cours sur des poissons, des poulets et des cochons, ainsi que sur des animaux de compagnie. Des essais avec d'autres types d'enzymes, qui coupent les protéines, sont également prévus pour les applications en nutrition humaine.
L'objectif d'Algolife est d'exploiter le plus de biomasse possible pour optimiser la valorisation des algues. Les chercheurs de la Station biologique de Roscoff utilisent une plate-forme de criblage pour tester l'activité des extraits d'algues sur des cellules avant de les tester sur des modèles animaux. Ils cherchent également à comprendre le mode d'action de ces extraits afin de maximiser leurs effets sur le système immunitaire.
Si les résultats des essais sont concluants, les algues pourraient devenir une alternative aux antibiotiques pour stimuler les défenses immunitaires et réduire la fréquence des maladies chez les humains et les animaux. Cela pourrait avoir un impact majeur sur la santé publique et l'élevage, en réduisant l'utilisation d'antibiotiques et en favorisant des méthodes plus naturelles et durables pour renforcer notre système immunitaire.
C.Groos

Nous en consommons sans le savoir
Il a été constaté qu'il existe actuellement plusieurs centaines d’espèces différentes d'algues, mais, seules une trentaine d'entre elles sont réellement exploitées. Cependant, il est intéressant de noter que nous consommons certaines de ces algues sans le savoir.
La plus connue : L'agar-agar, un épaississant d'origine végétale, gélatine, est un substitut parfait aux gélifiants d'origine animale. En plus de son action épaississante dans les préparations culinaires, il est également connu pour son effet sur la satiété, sans pour autant contenir de calories. En raison de ses propriétés minceur, il est souvent utilisé dans les régimes alimentaires. Sous le nom d'agérophytes,
L’agar-agar, est
riche en nutriments, tels que le fer et le magnésium.

Un exemple bien connu également, est celui des carraghénanes, ces algues rouges utilisées dans la fabrication de nombreux produits laitiers industriels. Elles sont responsables de la texture gélifiée de ces produits et sont répertoriées sous le code E407 dans la classification des additifs alimentaires. Le carraghénane est parfait pour épaissir la préparation de yaourts, de flans ou de crèmes desserts . Les carraghénanes sont des polysaccharides obtenus à partir d’algues rouges Ils sont incolores, inodores, sans saveur, et employés comme épaississants et gélifiants par l’industrie alimentaire
Nous en avons tous consommé sans le savoir, car l’algue marine a énormément de qualités a exploiter dans notre alimentation a venir.
Les alginates, quant à elles, sont extraites d'algues brunes et sont présentes dans des aliments tels que les glaces, les sauces et les plats préparés. Elles ont la capacité de former des gels solides et sont également utilisées pour l'encapsulation de médicaments. L'alginate est utilisé en raison de sa capacité à absorber rapidement l'eau, ce qui en fait un additif précieux dans divers produits déshydratés, tels que les produits amincissants, ainsi que dans la production de papier et de textiles. De plus, il est utilisé pour imperméabiliser les tissus et les rendre ignifuges. Dans l'industrie alimentaire, l'alginate joue un rôle d'agent épaississant dans les boissons, les crèmes glacées et les cosmétiques. Il est également utilisé comme agent gélifiant dans la préparation de gelées.
C.Groos

🌿 Les Algues Alimentaires Marines : Une Révolution Protéique Durable
Les algues marines comestibles suscitent un intérêt croissant en tant que super-aliments durables et riches en nutriments. Une étude récente menée par l'Université de technologie de Chalmers en Suède a mis en lumière le potentiel de la laitue de mer (Ulva fenestrata) comme source alternative de protéines de haute qualité. [1]
🧬 Une Innovation dans l'Extraction des Protéines
Traditionnellement, l'extraction des protéines des algues était complexe en raison de leur structure cellulaire. Cependant, les chercheurs ont développé une méthode innovante permettant d'extraire trois fois plus de protéines que les techniques précédentes. Cette avancée ouvre la voie à l'intégration des protéines d'algues dans divers produits alimentaires, tels que les substituts de viande et les smoothies protéinés. [1]
🌱 Un Profil Nutritionnel Remarquable
Outre leur teneur en protéines, les algues comme la laitue de mer sont riches en vitamine B12 et en acides gras oméga-3. Cette combinaison unique positionne les algues comme une solution nutritionnelle complète pour une alimentation équilibrée. [1]
🌊 Une Culture Écologiquement Responsable
La culture des algues présente des avantages environnementaux significatifs :
- Pas besoin d'eau douce, de fertilisants ni de pesticides.
- Absorption du dioxyde de carbone, contribuant à la réduction des gaz à effet de serre.
- Restauration des écosystèmes marins en fournissant des habitats pour la faune aquatique.
Ces caractéristiques font des algues une option alimentaire durable face aux défis du changement climatique. [2]
https://www.lequotidienaunaturelshop.com
Sources :
1. ScienceDaily: www.sciencedaily.com/releases/2024/11/241113123502.htm
2. FoodNavigator-USA.com: www.foodnavigator-usa.com/Article/2024/05/10/Kelp-seaweed-Is-this-the-next-superfood-trend/
#AlguesMarines #ProtéinesVégétales #SuperAliment #NutritionDurable #InnovationAlimentaire #ÉcologieCulinaire
Le réchauffement climatique et l'algue Marine.
___
Le réchauffement climatique a des conséquences significatives sur les algues marines, affectant leur biodiversité ainsi que les écosystèmes dont elles font partie.
Tout d'abord, le réchauffement des océans impacte les algues marines enmodifiant leur distribution géographique. Certaines espèces d'algues, qui sont adaptées à des températures spécifiques, pourraient ne plus trouver les conditions favorables à leur survie et pourraient donc disparaître de certaines régions. En même temps, de nouvelles espèces d'algues pourraient apparaître ou coloniser des zones où elles n'étaient pas présentes auparavant. Cela pourrait conduire à des changements dans la composition des communautés d'algues et perturber l'équilibre écologique.
De plus, le réchauffement climatique peut entraîner une augmentation des tempêtes et des événements climatiques extrêmes. Ces perturbations peuvent endommager gravement les populations d'algues marines en les arrachant des rochers ou en les déplaçant vers des zones où elles ne peuvent pas survivre. Cela peut entraîner une diminution de la biodiversité et de l'abondance des algues marines.
Le réchauffement climatique a également un impact sur les conditions environnementales nécessaires à la croissance et à la reproduction des algues marines. Par exemple, une augmentation de la température de l'eau peut entraîner une diminution de la disponibilité des nutriments, ce qui limite la croissance des algues. De plus, le pH de l'eau peut être modifié en raison de l'absorption accrue de dioxyde de carbone par les océans, ce qui peut affecter la capacité des algues à construire leurs coquilles ou leurs parois cellulaires.
Pour préserver la biodiversité des algues marines face au réchauffement climatique, plusieurs solutions sont envisageables. Tout d'abord, il est important de réduire les émissions de gaz à effet de serre pour limiter le réchauffement climatique lui-même. Cela peut être réalisé en adoptant des politiques de réduction des émissions et en favorisant les énergies renouvelables.
Ensuite, il est nécessaire de mettre en placedes mesures de protection et de gestion durable des écosystèmes marins, y compris les habitats d'algues. Cela peut inclure la création de réserves marines, la réglementation de la pêche et de l'exploitation des ressources marines, ainsi que la sensibilisation et l'éducation du public sur l'importance de la préservation de la biodiversité marine.
Enfin, des recherches et des études scientifiques sont nécessaires pour mieux comprendre les impacts du réchauffement climatique sur les algues marines et pour développer des stratégies d'adaptation et de résilience. Cela peut inclure des programmes de surveillance de l'état des populations d'algues, des études sur l'adaptation génétique des algues aux changements environnementaux, ainsi que des recherches sur les effets des mesures de gestion et de restauration des écosystèmes marins.
En conclusion, le réchauffement climatique a des conséquences significatives sur les algues marines, avec des impacts sur leur distribution, leur abondance, leur croissance et leur reproduction. Pour préserver leur biodiversité, il est nécessaire de réduire les émissions de gaz à effet de serre, de mettre en place des mesures de protection et de gestion durable des écosystèmes marins, ainsi que de mener des recherches pour mieux comprendre et gérer ces impacts.
C.Groos

Les algues marines jouent un rôle crucial dans la limitation des impacts du réchauffement climatique sur les océans, tels que l'acidification, la désoxygénation et la menace sur la biodiversité marine. En effet, elles absorbent une quantité importante de carbone,
ce qui équivaut à la capacité des forêts primaires à absorber les
gaz à effet de serre.
Au-delà de leur utilisation dans l'alimentation, de plus en plus de pays reconnaissent les avantages de la culture des algues. Par exemple, cette pratique pourrait contribuer au captage et au recyclage du CO2 émis par l'industrie. Cette opportunité a conduit à la création de la coalition Safe Seaweed, la première institution internationale dédiée
à la valorisation des algues marines.
L'objectif de cette institution est de rassembler et sensibiliser les différents acteurs de la filière algues (producteurs, industriels, chercheurs, gouvernance, associations) à l'échelle mondiale. Cette collaboration permettra d'établir des normes et des standards internationaux.
Dans ce contexte, il est essentiel de se préoccuper du développement de l'algoculture qui représente un véritable espoir dans la lutte contre le réchauffement climatique.
L’iode, les algues et le végétalisme
L'iode est un oligo-élément essentiel pour le bon fonctionnement de la thyroïde. Une carence en iode peut entraîner des problèmes tels qu'un goitre ou une hypothyroïdie. En France, la population générale présente une carence légère en iode. Les besoins quotidiens en iode pour un adulte sont d'environ 150 microgrammes.
Le végétalisme est une pratique alimentaire qui exclut les produits d'origine animale, qu'ils proviennent d'animaux morts ou vivants. Les personnes suivant un régime végétalien sont généralement déficientes en iode, il est donc recommandé de leur conseiller une alimentation riche en iode pour assurer des apports suffisants. Cependant, il est important de maintenir un apport en iode adéquat, car une carence ou une surconsommation peuvent avoir des effets néfastes sur la santé. L'OMS a fixé la limite de sécurité pour l'apport quotidien en iode à 1100 µg.
La consommation d'algues, en particulier les algues marines telles que le kombu, le wakamé, le haricot de mer, la dulse, le nori, ou la laitue de mer, permet d'augmenter l'apport en iode. Cependant, il est important d'être prudent, car la teneur en iode des algues peut varier d'un produit à l'autre. Il est essentiel de lire attentivement les étiquettes, car la concentration en iode peut grandement varier en fonction de la qualité des produits.
Les algues marines sont également riches en fer, protéines, calcium, sodium et iode. Par exemple, le wakamé contiendrait 10 fois plus de calcium que le lait, la laitue de mer serait 25 fois plus riche en fer que le bœuf et le varech contiendrait de 100 à 500 fois plus d'iode que les fruits de mer. C'est pourquoi elles peuvent être un atout précieux dans une alimentation végétalienne. Elles renferment également d'autres nutriments et composants tels que le magnésium, le potassium, le sodium, le sélénium, le manganèse, le zinc, le cuivre, les antioxydants, les vitamines C, E, K, les vitamines B, le fluor, les fibres solubles et les polysaccharides.
C.Groos

Photo Florence de Larochelambert
Les algues marines,une autre facette intéressante : un potentiel prometteur pour les biocarburants
L'énergie renouvelable est devenue un enjeu important afin de limiter notre dépendance aux sources d'énergie fossiles. Dans cette quête, les algues marines sont une solution prometteuse en tant que sources alternatives pour la production d'énergie.
1. Le potentiel énergétique des algues marines :
Les algues marines sont connues pour leur capacité à convertir la lumière solaire en énergie chimique par la photosynthèse. Comparativement aux plantes terrestres,les algues ont une croissance plus rapide et peuvent accumuler des quantités de biomasse bien plus élevées. Leur taux de croissance élevé, leur capacité à absorber le dioxyde de carbone (CO2) et leur tolérance à des conditions environnementales variables font des algues marines une ressource extrêmement prometteuse pour la production d'énergie.
2. La production d'énergie à partir des algues marines :
La production d'énergie à partir des algues marines peut être effectuée de différentes manières : la conversion de la biomasse en biocarburants liquides ou gazeux, ou encore la production d'électricité via les micro algues. Plusieurs techniques ont été développées pour exploiter ce potentiel énergétique, telles que la fermentation anaérobie, la pyrolyse, la gazéification ou encore l'hydrotraitement.
La fermentation anaérobie est un procédé permettant de transformer les algues en biogaz, composé de méthane et de dioxyde de carbone. Cette méthode est déjà employée à titre expérimental pour la production d'électricité et de chaleur.
La pyrolyse et la gazéification sont des procédés qui permettent de transformer les algues en biocarburants liquides ou gazeux. Ces procédés sont encore en cours de développement, mais des études ont montré leur capacité à produire des carburants similaires aux produits pétroliers classiques.
L'hydro traitement est une technique qui permet de convertir les lipides extraits des algues en biocarburants de deuxième génération. Ces biocarburants ont une composition chimique similaire aux carburants fossiles, ce qui les rend plus compatibles avec les infrastructures de stockage et de transport existantes.
3. Les avantages des biocarburants à base d'algues marines :
Les biocarburants dérivés des algues marines présentent de nombreux avantages par rapport aux biocarburants classiques issus des cultures terrestres. Tout d'abord, les cultures d'algues marines ne nécessitent pas de terres arables. De plus, les algues marines peuvent être cultivées dans des eaux salées ou saumâtres,réduisant ainsi l'utilisation de l'eau douce précieuse.
De plus, les algues peuvent être cultivées sur des terres non productives ou dans des installations côtières, minimisant les impacts sur les écosystèmes terrestres. Autre avantage, ces cultures peuvent contribuer à la dépollution en absorbant les contaminants tels que le CO2, les oxydes de soufre et les nitrates.
Enfin, les biocarburants à base d'algues préservent la biodiversité en évitant la fragmentation des habitats naturels, contrairement aux cultures terrestres intensives.
En synthèse :
Les possibilités de production d'énergie à partir des algues marines et leur utilisation dans les biocarburants offrent une alternative prometteuse et durable aux énergies fossiles. Les faits prouvés révèlent le potentiel élevé de croissance des algues marines et leurs avantages multiples en termes de rentabilité énergétique et environnementale. .
C.Groos
Les algues marines et leur beauté envoûtante :
Les algues marines sont souvent associées à des sujets scientifiques et environnementaux, mais saviez-vous qu'elles jouent également un rôle crucial dans le monde de l'art ? Les artistes du monde entier ont découvert les merveilles esthétiques et créatives que les algues marines peuvent offrir. Dans cet article, plongeons dans l'univers fascinant des applications artistiques des algues marines et découvrez comment ces organismes marins peuvent inspirer des installations artistiques originales.
L'algue marine comme matériau de création:
Imaginez des sculptures délicates et élégantes faites entièrement d'algues marines. De nombreux artistes ont expérimenté avec ces organismes marins uniques pour créer des pièces d'art à couper le souffle. Les algues, avec leurs formes variées et leurs couleurs vibrantes, peuvent être tissées, tressées et façonnées pour créer des structures complexes et intemporelles. Les résultats sont étonnants, car ils transmettent une sensation de légèreté et de fluidité tout en évoquant la beauté de l'océan.
Installation artistique inspirée des algues marines:
Les algues marines sont une source d'inspiration inépuisable pour de nombreux artistes. Leur mouvement gracieux dans l'eau, leur texture ondulante et les nombreuses nuances de couleur qu'elles revêtent ont été à l'origine de nombreuses installations artistiques uniques. Ces installations, souvent réalisées en collaboration avec des scientifiques marins, permettent aux spectateurs de plonger dans un monde imaginaire où les algues marines prennent vie.


L'art comme moyen de sensibilisation :
En utilisant les algues marines dans leurs créations artistiques, les artistes ont également contribué à sensibiliser le public à l'importance de ces organismes pour l'écosystème marin. Leur utilisation créative des algues rappelle aux spectateurs la fragilité de l'environnement marin et les invite à réfléchir à l'impact de leurs actions sur cet écosystème vital. L'art devient ainsi un puissant moyen de sensibilisation et d'éducation sur les enjeux environnementaux.
En synthèse :
Les applications artistiques et esthétiques des algues marines sont une preuve supplémentaire de la richesse et de la diversité de la nature. Les artistes, en utilisant ces organismes marins comme matériau de création et source d'inspiration, nous rappellent la nécessité de préserver nos océans et leur biodiversité. Que ce soit à travers des sculptures délicates ou des installations grandioses, l'art des algues marines nous transporte dans un monde enchanteur où la beauté de la nature se mêle à la créativité humaine.
Deux tableaux de Nicole Delaval , a base d'algues amrines.
Les zones Natura 2000 en mer.
---
Les zones Natura 2000 en mer ont été établies pour protéger la biodiversité marine et préserver les écosystèmes fragiles dans les eaux européennes. Des recherches approfondies montrent comment l'établissement de ces zones protégées contribue à soutenir la biodiversité marine et à garantir un avenir durable pour les générations futures.
La biodiversité marine est essentielle pour maintenir l'équilibre écologique des océans et jouer un rôle clé dans la lutte contre le changement climatique. Les zones Natura 2000 ont été créées sous la directive européenne "Oiseaux" et "Habitat" pour protéger et préserver certains habitats et espèces marines remarquables.
Les zones Natura 2000 en mer couvrent les espaces marins protégés dans les eaux territoriales des États membres de l'Union européenne. Elles incluent une grande variété d'habitats, tels que les récifs coralliens, les prairies marines, les estuaires, les lagunes et les zones côtières. Ces zones abritent une biodiversité remarquable et accueillent de nombreuses espèces d'oiseaux, de poissons, de mammifères marins et d'invertébrés.
Les bénéfices des zones Natura 2000 en mer : elles jouent un rôle crucial dans la conservation de la biodiversité marine. Elles permettent de protéger les habitats et les espèces menacés, de restaurer les écosystèmes dégradés et de maintenir des populations viables d'espèces clés. En protégeant les aires de reproduction, de nourrissage et de migration des espèces marines, ces zones contribuent également à maintenir les écosystèmes marins sains et résistants.
Cependant, l'établissement et la gestion des zones Natura 2000 en mer ne sont pas sans défis. Les activités humaines telles que la pêche, l'exploitation minière, le transport maritime et le tourisme peuvent avoir un impact négatif sur ces zones protégées. Des synergies entre les acteurs concernés, y compris les scientifiques, les pêcheurs, les gestionnaires des ressources marines et les décideurs politiques, sont nécessaires pour concilier les intérêts économiques et environnementaux.
Des approches innovantes telles que la création de zones tampons, la réglementation de l'usage des ressources marines et la promotion de pratiques durables peuvent contribuer à résoudre ces défis. En outre, la sensibilisation du public et l'éducation environnementale sont essentielles pour promouvoir la compréhension et l'importance de la préservation de la biodiversité marine.
en synthése : Les zones Natura 2000 en mer sont un précieux outil de conservation de la biodiversité marine. Leur établissement est essentiel pour maintenir des océans en bonne santé et pour garantir un avenir durable. Les solutions aux défis auxquels ces zones sont confrontées nécessitent la coopération, la participation et l'engagement de tous les acteurs concernés. Grâce à ces efforts communs, il est possible de préserver la richesse naturelle de nos mers pour les générations futures.
C.Groos




Macro-algues : leur utilisation environnementale et durable.
Les macro-algues, ou algues marines, sont des organismes végétaux qui jouent un rôle crucial dans les écosystèmes marins. Leur étude et leur compréhension sont essentielles pour évaluer leur impact sur l'environnement.
L
es macro-algues jouent un rôle important dans le cycle des éléments nutritifs. Elles absorbent des nutriments tels que le phosphore et l'azote présents dans l'eau, contribuant ainsi à réduire l'eutrophisation, un phénomène dans lequel un excès de nutriments dans l'eau peut entraîner une prolifération d'algues nuisibles. En absorbant ces nutriments, les macro-algues limitent la disponibilité de ceux-ci pour les algues nuisibles, contribuant ainsi à maintenir un équilibre écologique.
De plus, les macroalgues jouent un rôle important dans la qualité de l'eau. En filtrant l'eau dans laquelle elles se trouvent, elles éliminent les substances toxiques et les particules en suspension. Cela contribue à maintenir la transparence de l'eau et à réguler l'équilibre chimique de l'écosystème marin. Par conséquent, les macro-algues peuvent être considérées comme une sorte de purificateur d'eau naturel, contribuant à la santé des écosystèmes marins.
En outre, les macro-algues peuvent jouer un rôle crucial dans la lutte contre la pollution. Elles ont la capacité de bio-accumuler certains polluants, comme les métaux lourds, en les absorbant dans leurs tissus. En retirant ces polluants de l'eau, elles contribuent à la dépollution de l'environnement marin. Cela ouvre des possibilités prometteuses dans la lutte contre la pollution marine, car les macro-algues peuvent être utilisées comme des phytoremédiatrices naturelles pour éliminer les polluants présents dans les écosystèmes côtiers.
(La phytoremédiation : dépollution par les plantes, des eaux et sols )
Elles ont également des interactions étroites avec d'autres organismes marins. Elles offrent un habitat et une source de nourriture à de nombreuses espèces, ce qui contribue à la biodiversité marine. Les macro algues fournissent des refuges, des sites de reproduction et des sources d'alimentation pour les poissons, les crustacés et les invertébrés marins. Elles sont également un support vital pour de nombreux organismes tels que les coraux et les éponges.
Enfin, l'utilisation durable des macro algues présente des avantages potentiels pour les êtres humains. Elles sont utilisées depuis des siècles dans l'alimentation humaine, notamment en Asie et en Europe. Elles sont également utilisées dans l'industrie pharmaceutique, la cosmétique et l'agriculture. Leur utilisation durable peut donc offrir des avantages économiques importants tout en préservant les écosystèmes marins.
En conclusion, l'étude des effets des macro algues sur l'environnement et les écosystèmes révèle leur rôle important dans le cycle des éléments nutritifs, la qualité de l'eau, la lutte contre la pollution et les interactions avec d'autres organismes marins. Comprendre et préserver ces organismes marins est essentiel pour maintenir l'équilibre écologique des écosystèmes marins et exploiter de manière durable les nombreux avantages qu'ils offrent.
C.Groos
L'interaction entre les algues marines et les autres espèces dans les écosystèmes marins.
Les algues marines jouent un rôle crucial dans les écosystèmes marins en interagissant avec les autres espèces de différentes manières. Leur présence a une importance majeure,et leur activité ont des répercussions sur la biodiversité et la stabilité de ces habitats.
Les algues marines fournissent un habitat et une protection pour de nombreuses espèces, en offrant des sites de reproduction, de nourriture et de protection ; elles sont également utiles pour protéger certaines espèces des prédateurs.
Les algues brunes,rouges et vertes abritent une grande diversité de petits organismes tels que les crustacés, les mollusques et les poissons juvéniles. Ces organismes trouvent refuge parmi les frondes d'algues, se camouflant et se nourrissant des différentes espèces d'algues présentes. En retour, certaines espèces marines, comme les poissons opportunistes et les mollusques, peuvent se nourrir des algues, contribuant ainsi à maintenir un équilibre dans l'écosystème.
Les algues marines sont une source importante de nutriments pour de nombreuses espèces marines. Elles produisent de la matière organique par photosynthèse,fournissant de la nourriture pour les herbivores. Les algues mortes et en décomposition sont également consommées par des organismes décomposeurs tels que des bactéries et des invertébrés, contribuant également, au recyclage des nutriments dans l'écosystème.
Les algues marines jouent un rôle crucial dans le maintien de la qualité de l'eau. Elles absorbent les nutriments en excès tels que les nitrates et les phosphates, provenant de l'agriculture et des eaux usées, contribuant ainsi à réduire la pollution et à prévenir les proliférations d'algues nuisibles.
Les algues marines jouent un rôle crucial dans le maintien de la qualité de l'eau. Elles absorbent les nutriments en excès tels que les nitrates et les phosphates, provenant de l'agriculture et des eaux usées, contribuant ainsi à réduire la pollution et à prévenir les proliférations d'algues nuisibles.
Les interactions entre les algues marines et les autres espèces marines sont diverses. Certaines espèces d'algues peuvent proliférer de manière excessive, formant des tapis d'algues qui étouffent les autres organismes présents dans l'écosystème. Ces proliférations peuvent entraîner des perturbations dans l'équilibre écologique de l'écosystème côtier, affectant la diversité des espèces et la productivité de l'écosystème.
L’interaction entre les algues marines et les autres espèces marines est complexe et variée,jouant un rôle essentiel dans la structure et le fonctionnement de ces éco systèmes, et offrant un habitat, de la nourriture et améliorent la qualité de l'eau.
Cependant, il est important de surveiller et de gérer les populations d'algues pour prévenir les déséquilibres écologiques et maintenir la biodiversité et la santé des écosystèmes côtiers.
Les algues peuvent également jouer un rôle dans la régulation du climat en absorbant le dioxyde de carbone de l'atmosphère et en contribuant à réduire l'acidification des océans.
Elles peuvent aussi aider à stabiliser les fonds marins en absorbant les nutriments et en limitant l'érosion côtière.
Les algues alimentaires produites et commercialisées en France, sont étroitement surveillées et analysées en laboratoire, afin de correspondre aux obligations sanitaires et alimentaires. Elles sont récoltées ou cultivées dans des zones protégées (Natura 2000 par exemple) et/ou surveillées.
C.Groos

Le Chondrus breton : une algue aux
qualités peu connues du grand public, en alimentation.
- Connue également sous le nom de mousse d'Irlande ou de mousse de mer, le Chondrus breton est une macro-algue marine qui pousse principalement sur les côtes de Bretagne. Très appréciée pour son goût délicat et ses nombreux bienfaits sur la santé, cette algue est de plus en plus utilisée en alimentation.
- Tout d'abord, le Chondrus breton est riche en nutriments essentiels. Il contient notamment une grande quantité de fibres, de protéines et de minéraux tels que le calcium, le magnésium et le fer. Les fibres présentes dans cette algue favorisent le transit intestinal et participent ainsi au bon fonctionnement du système digestif. De plus, les protéines qu'elle renferme sont de haute qualité et peuvent être utilisées comme une excellente alternative aux sources de protéines animales.
- En plus de ses valeurs nutritionnelles, le Chondrus breton possède également des propriétés bénéfiques pour la santé. En effet, cette algue est riche en antioxydants qui aident à lutter contre les radicaux libres responsables de diverses maladies. Elle est également reconnue pour ses propriétés anti-inflammatoires qui peuvent soulager certains troubles inflammatoires tels que l'arthrite et les problèmes articulaires.
- De plus, le Chondrus breton est également une excellente source de vitamine C, qui joue un rôle crucial dans le renforcement du système immunitaire et la prévention des infections. En consommant régulièrement cette algue, vous pouvez ainsi contribuer à renforcer votre système immunitaire et prévenir les maladies saisonnières.
- Outre ses qualités nutritionnelles et santé, le Chondrus breton peut également être utilisé dans différentes préparations culinaires. En effet, cette algue peut être intégrée dans de nombreuses recettes, aussi bien salées que sucrées. Sa texture légèrement croquante et son goût subtil s'accordent à merveille avec les salades, les soupes, les sauces et même les desserts tels que les crèmes et les confitures.
- De plus, le Chondrus breton est également utilisé comme épaississant naturel dans de nombreux produits alimentaires tels que les yaourts, les sauces et les crèmes dessert. Sa capacité à former un gel au contact d'un liquide en fait un ingrédient de choix pour épaissir et donner une texture agréable à vos préparations. En fait, sans le savoir, vous en consommez sans doute régulièrement.
- Enfin, il convient de souligner que le Chondrus breton est également respectueux de l'environnement. En effet, sa culture nécessite peu d'énergie, ce qui en fait une culture durable et écologique. De plus, cette algue contribue à préserver la biodiversité marine en offrant un habitat naturel à de nombreuses espèces.
- En conclusion, le Chondrus breton est une algue aux multiples qualités qui mérite d'être intégrée dans votre alimentation. Riche en nutriments essentiels, même si elle est moins fine gustativement que d’autres macro-algues, bénéfique pour la santé et adaptable en cuisine, cette algue marine offre de nombreuses possibilités culinaires. Que vous souhaitiez renforcer votre système immunitaire, améliorer votre transit intestinal ou simplement diversifier votre alimentation, le Chondrus breton est l'ingrédient idéal à adopter (en particulier pour les sportifs qui sollicitent leurs articulations.). Alors, n'attendez plus et découvrez les bienfaits de cette algue bretonne!
- C.Groos

Les algues et la santé
Les algues marines alimentaires, ou algues comestibles, ont longtemps été consommées dans les régions côtières du monde entier. Cependant, ces dernières années, les recherches sur les bienfaits des algues marines alimentaires pour la santé ont suscité un intérêt croissant parmi les scientifiques et le grand public. De nombreuses recherches ont été menées ces dernières années pour étudier les propriétés bénéfiques des algues marines dans l'alimentation.
Elles sont une excellente source de minéraux tels que le calcium, le magnésium et le fer,ainsi que de vitamines, notamment la vitamine A, C ou K. Les algues sont aussi, riches en acides aminés essentiels, en fibres et en antioxydants, ce qui en fait un aliment complet et bénéfique pour la santé.
Plusieurs études ont montré que la consommation régulière d'algues marines peut contribuer à la prévention de diverses maladies. Elles ont également été étudiées pour leurs effets positifs sur la santé gastro-intestinale en favorisant la croissance des bactéries bénéfiques dans l'intestin. Les algues marines alimentaires ont également montré des propriétés anti-inflammatoires, antivirales, antioxydantes et anticancéreuses. Une étude publiée dans la revue "Food Chemistry"a
montré que les algues brunes, telles que le wakamé et le kombu, ont des propriétés antioxydantes plus puissantes que certaines baies, comme les myrtilles.
De plus, une autre étude publiée dans "Marine Drugs" a montré que certaines
algues rouges, telles que l'algue nori,
ont des composés bioactifs qui pourraient être efficaces contre le cancer.
Une étude publiée dans le Journal of Applied Phycology en 2017 a notamment mis en lumière les effets positifs des algues marines sur la prévention et le traitement de certaines maladies. Les chercheurs ont constaté que la consommation régulière d'algues peut aider à réduire le risque de maladies cardiovasculaires, d'obésité et de diabète de type 2. Elles sont également reconnues pour leur capacité à renforcer le système immunitaire et à améliorer la santé de la peau.
Une autre étude, parue dans le Journal of Agricultural and Food Chemistry en 2016, a mis en évidence les propriétés anti-inflammatoires des algues marines. Les chercheurs ont découvert que certaines molécules présentes dans les algues marines peuvent aider à lutter contre l'inflammation chronique, qui est à l'origine de certaines maladies.
Une étude publiée dans Food Chemistry en 2018 a montré que les algues marines contiennent des composés bioactifs ayant des effets positifs sur la santé digestive. En effet, ces composés peuvent favoriser la croissance des bonnes bactéries intestinales et ainsi améliorer la santé du microbiote intestinal.

En plus de leurs bienfaits pour la santé, les algues marines alimentaires présentent aussi un intérêt écologique et économique. Leur culture est souvent plus durable que celle des cultures terrestres, car elles nécessitent moins der essources en eau douce et n'ont pas besoin d'engrais ni de pesticides. Elles peuvent être cultivées dans des zones côtières où les terres agricoles sont rares, ce qui peut contribuer à la sécurité alimentaire et à la création d'emplois dans les régions côtières.
Elles sont également étudiées comme alternative aux sources de protéines animales. En raison de leur teneur élevée en protéines et de leur faible empreinte carbone, les algues pourraient être une solution pour répondre aux besoins en protéines de la population mondiale tout en réduisant l'impact environnemental de l'élevage intensif.
Les recherches au sujet des algues marines alimentaires sont prometteuses et soulignent l'importance de les intégrer dans une alimentation équilibrée. Leur richesse en nutriments et leurs nombreux bienfaits pour la santé en font un aliment à la fois délicieux et bénéfique pour notre organisme. Cependant,malgré tous ces bénéfices potentiels, il est important de noter que certaines algues peuvent contenir des niveaux élevés de métaux lourds et de contaminants,en particulier celles récoltées dans des eaux polluées.
Il est donc essentiel de s'approvisionner en algues marines alimentaires auprès de sources fiables
L’algue Marine : une alliée pour l’équilibre du corps.
Les algues marines possèdent de nombreuses qualités médicinales, notamment :
1. Riches en nutriments : Les algues marines sont une excellente source de vitamines, de minéraux et d'antioxydants essentiels pour une bonne santé.
2. Bonne source d'iode : Les algues marines sont une des meilleures sources naturelles d'iode, un élément essentiel à la fonction thyroïdienne.
3. Anti-inflammatoires : Les algues marines contiennent des composés anti-inflammatoires tels que les polyphénols, qui peuvent aider à réduire l'inflammation et à soulager les symptômes de conditions inflammatoires telles que l'arthrite.
4. Action antivirale : Certains types d'algues marines, tels que les algues brunes, contiennent des composés antiviraux naturels qui peuvent aider à inhiber la réplication des virus et à renforcer le système immunitaire.
5. Action antioxydante : Les algues marines sont riches en antioxydants tels que les caroténoïdes et les flavonoïdes, qui peuvent aider à neutraliser les radicaux libres et à réduire le stress oxydatif dans l'organisme.
6. Effets cardio-protecteurs : Certaines algues marines, comme les algues rouges, sont connues pour leur capacité à réduire le taux de cholestérol et à améliorer la santé cardiovasculaire.
7. Effets anticancéreux : Les algues marines contiennent des composés bioactifs tels que les polysaccharides et les phycobiliprotéines, qui ont démontré des propriétés anticancéreuses et peuvent aider à prévenir la croissance des cellules cancéreuses.
Il convient de noter que ces qualités médicinales peuvent varier en fonction du type d'algue marine et de sa composition spécifique.
Par conséquent, il est bon de consulter un professionnel de la santé avant de consommer des algues marines à des fins spécifiquement médicinales.
C.Groos

L’algue marine est indispensable en milieu océanique.
Les algues marines sont des organismes photosynthétiques qui se développent dans les océans et autres plans d'eau salée. Elles appartiennent au règne des Protistes et comprennent des organismes unicellulaires et multicellulaires.
Ces algues jouent un rôle crucial dans l'écosystème océanique en produisant de l'oxygène grâce à la photosynthèse. Elles convertissent la lumière solaire en énergie chimique, ce qui leur permet de produire leur propre nourriture. Ce processus est similaire à celui des plantes terrestres.
On distingue différents types d'algues marines, notamment les algues microscopiques (phytoplancton) et les algues macroscopiques (macroalgues). Le phytoplancton constitue souvent la base de la chaîne alimentaire marine car il est consommé par de nombreux organismes, tels que les poissons et les zooplanctons. Les macroalgues, comme les algues brunes et les algues rouges, sont généralement ancrées au fond de l'océan et créent des habitats complexes pour de nombreux animaux.
Outre leur rôle dans la production d'oxygène, les algues marines sont également importantes pour la régulation du climat. Elles absorbent le dioxyde de carbone atmosphérique, limitant ainsi son impact sur le réchauffement climatique. De plus, elles agissent comme des filtres chimiques en absorbant et en éliminant les nutriments excédentaires tels que les nitrates et les phosphates, ce qui aide à prévenir les proliférations d'algues nocives.
Les algues marines ont des applications commerciales significatives. Elles sont utilisées dans l'industrie alimentaire comme ingrédients dans les produits tels que les algues séchées et les extraits d'algues. Elles sont également utilisées dans l'industrie cosmétique pour la production de crèmes solaires et de produits de soins de la peau.
En conclusion, les algues marines jouent un rôle essentiel dans les écosystèmes océaniques en fournissant de l'oxygène, en régulant le climat et en ayant des applications commerciales importantes. Il est donc crucial de comprendre et de gérer leur rôle dans l'équilibre écologique afin de préserver la santé des océans.
C.Groos
L’algo culture est Eco durable
Les algues marines, autrefois considérées comme de simples "herbes marines", sont aujourd'hui reconnues comme une alternative écologique prometteuse aux ingrédients alimentaires traditionnels. Ces organismes aquatiques, souvent négligés, présentent en réalité un potentiel considérable pour répondre à nos besoins alimentaires tout en préservant l'environnement.
L'utilisation des algues marines présente de nombreux avantages. En premier lieu, elle permet de réduire la dépendance aux ressources terrestres. Par rapport aux cultures terrestres, les algues nécessitent seulement une fraction de l'espace pour produire la même quantité de protéines, d'acides aminés et de minéraux. De plus, elles n'ont pas besoin d'engrais, de pesticides ni de terres fertiles pour se développer. En somme, les algues marines représentent une solution durable pour nourrir une population mondiale en constante croissance, tout en préservant les ressources de notre planète.
Un autre avantage majeur réside dans la préservation des écosystèmes marins. En utilisant les algues marines comme ingrédients alimentaires, nous réduisons la pression exercée sur les stocks de poissons et autres espèces marines, souvent surexploités. En optant pour les algues, nous offrons aux océans l'opportunité de se régénérer et de maintenir leur biodiversité. Par ailleurs, les algues servent d'habitats naturels et de nurseries pour de nombreuses espèces marines, favorisant ainsi leur survie et leur reproduction.
Un autre aspect clé des algues marines est leur capacité à capturer le carbone atmosphérique et à lutter contre le changement climatique. Grâce à la photosynthèse, les algues font partie des organismes les plus efficaces pour fixer le dioxyde de carbone (CO2). En capturant le CO2, elles contribuent à réduire la concentration de ce gaz à effet de serre dans l'atmosphère. De plus, lorsqu'elles sont récoltées et utilisées comme ingrédients alimentaires, elles stockent le carbone dans les produits finaux, évitant ainsi sa libération ultérieure lors de la décomposition des déchets alimentaires. Par conséquent, l'utilisation d'algues marines aide à atténuer le changement climatique en réduisant les émissions de gaz à effet de serre.
En conclusion, les algues marines offrent une alternative écologique aux ingrédients alimentaires traditionnels. Leur production nécessite peu de ressources terrestres, préserve les écosystèmes marins en réduisant la pression sur les stocks de poissons et capture le carbone atmosphérique pour lutter contre le changement climatique. En incorporant les algues marines dans notre alimentation, nous pouvons bénéficier de leurs nombreux avantages écologiques tout en contribuant à la préservation de notre planète.
C.Groos
Quels sont les atouts des algues marines?
En général, les algues marines, qu'elles soient vertes, brunes ou rouges, sont une source de fibres et de protéines. Elles contiennent peu de lipides et de glucides, ainsi que des vitamines, des minéraux et des antioxydants. Ces algues nous fournissent surtout des nutriments essentiels, qui sont indispensables à notre santé et que notre corps ne peut pas produire lui-même.
Les algues contiennent des protéines, y compris les 8 acides aminés essentiels. La quantité de protéines varie de 8 à 30% dans les algues séchées . Elles sont également une source d'acides gras essentiels tels que les oméga 6 et 3, comme l'acide linoléique et l'acide alpha-linolénique. Elles contiennent également des acides gras à très longues chaînes comme l'acide arachidonique (AA) et les oméga 3, qui sont indispensables pour la santé cardiovasculaire et mentale. En outre, les algues sont riches en minéraux et oligo-éléments tels que le calcium, le magnésium, le potassium, le soufre, le fer et le zinc. Elles fournissent également des oligo-éléments tels que l'iode, le cuivre, le sélénium, le molybdène, le fluor, le manganèse, le bore, le nickel et le cobalt, avec des concentrations plus élevées que celles des légumes verts. Les algues sont une source de vitamines, en particulier les vitamines A, E, K et les vitamines du complexe B telles que B1, B2, B9, B5 et C. En plus de cela, les algues contiennent des molécules antioxydantes telles que les caroténoïdes, les flavonoïdes et les acides phénoliques (tannins). Elles sont également riches en fibres solubles et insolubles, qui aident à capturer le cholestérol alimentaire, à réduire l'indice glycémique des repas, à favoriser un transit intestinal régulier et à soutenir le développement d'une flore intestinale bénéfique.
C.Groos
Source de Bienfaits
Les algues marines, sont riches en nutriments essentiels tels que les vitamines, les minéraux et les acides gras oméga-3, ce qui en fait des alliées pour notre santé globale.
Les propriétés anticancéreuses des algues sont notamment dues à leur teneur en composés bioactifs tels que les polysaccharides et les polyphénols, qui peuvent inhiber la croissance des cellules cancéreuses et favoriser leur apoptose. De même, leurs propriétés anti-inflammatoires contribuent à réduire l'inflammation dans notre corps, ce qui est bénéfique pour prévenir et traiter diverses maladies inflammatoires.
Les algues possèdent également des propriétés antivirales qui peuvent aider à combattre les infections virales, telles que le rhume et la grippe. Leurs propriétés analgésiques peuvent soulager la douleur et l'inconfort, tandis que leurs propriétés immunomodulatrices renforcent notre système immunitaire en stimulant la production de cellules immunitaires.
En outre, les algues ont des propriétés antibactériennes et antifongiques, ce qui peut aider à prévenir et à traiterles infections bactériennes et fongiques. Leurs composés actifs peuvent inhiber la croissance des bactéries et des champignons pathogènes, tout en préservant les bonnes bactéries présentes dans notre corps.
Enfin, la richesse en nutriments essentiels des algues en fait une excellente source de vitamines, de minéraux et d'acides gras oméga-3. Les vitamines, telles que la vitamine C et la vitamine E, sont des antioxydants puissants qui protègent nos cellules contre les dommages causés par les radicaux libres. Les minéraux, tels que le fer et le calcium, jouent un rôle crucial dans de nombreuses fonctions corporelles. Quant aux acides gras oméga-3, ils sont essentiels pour la santé du cerveau, du cœur et pour réduire l'inflammation.
En résumé, les algues offrent une multitude de bénéfices pour notre santé grâce à leurs propriétés anticancéreuses, anti-inflammatoires, antivirales, analgésiques, immunomodulatrices, antibactériennes et antifongiques. Leur richesse en nutriments essentiels en fit des alliées pour maintenir une santé optimale.
Merci les algues pour tous ces bienfaits !
C.Groos
Les algues : la source de vie
Les algues, en symbiose avec les bactéries, ont été les premiers êtres vivants à apparaître sur terre. Les macroalgues, quant à elles, ont été les premiers organismes multicellulaires, formant ainsi l'amorce de la vie. Il y a quelques centaines de millions d'années, les algues vertes ont quitté l'océan pour évoluer et donner naissance à la diversité végétale que nous connaissons. L'océan joue un rôle capital dans la naissance de la vie. Il est la source et l'origine de tous les organismes vivants. Les algues occupent une place essentielle dans cet écosystème, bien qu'elles soient souvent mal comprises. Cependant, compte tenu des enjeux climatiques et de la croissance démographique mondiale, il est crucial de réévaluer cette ressource oubliée.
Les algues, qui constituent le fondement de la vie marine, sont un point de départ essentiel et extrêmement prometteur si nous souhaitons restaurer nos écosystèmes océaniques et notre planète.
C.Groos

L’OCEAN et les algues marines
Le potager de l’avenir
Les algues se regroupent en trois grandes catégories en fonction de leur couleur due aux pigments qu'elles contiennent : brunes, rouges et vertes. Les algues sont de véritables trésors de vitamines A, B, C, D, E , de minéraux et oligo-éléments tels que l'iode, le calcium, le fer, le sodium, le magnésium, le phosphore, le potassium… Ces minéraux représentent environ 20% de leur poids sec. Certaines algues sont notamment riches en calcium, telles que le kombu, le wakamé, et la dulse, ce qui en fait une option intéressante pour ceux qui ne peuvent ou ne veulent pas consommer de produits laitiers. De plus, les algues,étant alcalinisantes, contribuent au bien-être des articulations en protégeant les os des effets néfastes d'un excès d'acides dans le corps.
Il est estimé qu'une consommation quotidienne de 100 g d'algues couvre nos besoins en vitamines. Il convient de noter qu'elles contiennent des quantités importantes de vitamine B12, absente des végétaux terrestres, très prisée par les végétariens pour prévenir l'anémie en favorisant la synthèse d'hémoglobine. Pour les personnes ne consommant pas de produits d'origine animale, les algues sont également intéressantes en raison de leur teneur en protéines, qui varie de 6 à 70% selon les espèces. Leur composition en acides aminés étant proche de celle des œufs et du lait, elles constituent une source qualitative de protéines à ne pas négliger.
Les algues sont naturellement pauvres en matières grasses (seulement 1 à 3%), mais elles contiennent des acides gras Oméga 3. Les algues sont également faibles en glucides (environ5%), mais riches en fibres, ce qui leur confère un effet coupe-faim naturel,favorise la détoxification intestinale, a une action prébiotique en favorisant la croissance des bonnes bactéries intestinales, et agit bénéfiquement sur le transit.Enfin, les algues renferment des substances antioxydantes protectrices telles que les polyphénols et les caroténoïdes.
La vaste famille des algues
Que ce soit brunes, rouges ou vertes, les algues ont tout bon !
Les algues brunes :
- Le kombu (ou laminaire) est riche en alginates, iode, sucre, brome, protéines, calcium, vitamine B12 et contient de l'acide glutamique, un exhausteur de goût naturel, d'où son utilisation dans les bouillons.
- Le wakamé, originaire d'Asie, est très présent en Bretagne . Son pied, appelé mékabu, est réputé pour ses effets détoxifiants et ses propriétés riches en fibres et en iode, ce qui en fait une alliée pour les personnes en surpoids.
- Les spaghettis de mer sont riches en iode, sodium, cobalt, vitamines C et E.
Les algues rouges :
- Le nori, également connu sous le nom de porphyre, est particulièrement riche en protéines.
- La dulse, est une excellente source de vitamine A et C.
Les algues vertes :
- La laitue de mer, très répandue sur les rochers entre autres, est riche en vitamine C et fer.
Les algues regorgent de molécules bio actives, telles que les fucoïdanes (Polysaccharide), qui présentent de multiples bienfaits pour la santé. Ces substances sont reconnues pour leurs propriétés antitumorales, antibiotiques, antioxydantes, antivirales et anti-coagulantes. De plus, les alginates présents dans les algues contribuent à protéger les système cardio-vasculaire et veineux, tout en aidant à réduire la pression sanguine et le taux de cholestérol.
Grâce à leur forte teneur en fibres, les algues peuvent également être bénéfiques pour prévenir le diabète en régulant le taux de sucre dans le sang.
Malgré certaines contre-indications à prendre en compte, telles que les troubles de la thyroïde liés à l'excès d'iode, les algues restent des alliés précieux pour la santé. Il est donc recommandé de se tourner vers des marques sérieuses et de demander des garanties sur la qualité des produits avant de les consommer. Sachant que le label BIO est dévolu a la Bretagne pour la qualité de ses eaux.
🧬 Découverte majeure : le génome des algues brunes dévoilé
Des chercheurs de la Station biologique de Roscoff (CNRS/Sorbonne Université) ont analysé 60 nouveaux génomes d'algues brunes. Cette étude révèle des innovations génomiques clés ayant permis l'adaptation des algues brunes aux environnements côtiers soumis aux marées. [1]
Ces avancées éclairent l'évolution de ces "forêts sous-marines" qui jouent un rôle crucial dans la séquestration du carbone et la résilience des écosystèmes côtiers. Les données génomiques sont accessibles via la plateforme Phaeoexplorer, offrant de nouvelles perspectives pour la conservation et l'exploitation durable des algues brunes. [1]
https://www.lequotidienaunaturelshop.com
# génomealgues # séquençagegénétique #algues#alguesalimentaires#alguesbretonnes#cuisinevégétale#healthyfood#umami
Source : 1. https://www.sb-roscoff.fr/fr/2024/12/12/une-plongee-dans-les-genomes-d-algues-brunes-revele-les-secrets-de-leur-evolution

Le goût Umami : qu’est-ce que c’est ?
Le goût umami est l'un des cinq goûts de base, aux côtés du sucré, du salé, de l'acide et de l'amer. Le mot "umami" vient du japonais et signifie "savoureux" ou "délicieux". Il est souvent décrit comme une sensation de "goût savoureux", "de satisfaction" ou "de plein".
Le goût umami est provoqué par la présence d'un acide aminé appelé glutamate. Cet acide aminé se trouve naturellement dans certains aliments tels que les viandes, les produits laitiers, les légumes, les champignons et les algues. Il peut également être créé par un processus de fermentation, comme dans le cas du fromage, de la sauce soja ou du miso.
Le goût umami est souvent décrit comme une sensation de "rond", "profond" ou "relevé". Il ajoute de la complexité et de la profondeur aux plats, en améliorant la saveur globale. Il peut également aider à rehausser les autres goûts, tels que le salé ou le sucré.
L'identification du goût umami a été largement attribuée au chercheur japonais Kikunae Ikeda, qui a découvert le glutamate en 1908. Depuis lors, le goût umami est devenu une sensation de plus en plus populaire dans la cuisine du monde entier, particulièrement dans la cuisine asiatique.
En résumé, le goût umami est une sensation de goût savoureux et satisfaisant qui est provoquée par la présence de glutamate dans certains aliments. Il ajoute de la complexité et de la profondeur aux plats, et peut être trouvé dans un large éventail d'aliments différents.
C.Groos
La Laitue de mer
La laitue de mer (Ulva lactuca) est présente en France. La laitue de mer, également connue sous le nom d'algue de mer ou d'algue verte, On la trouve essentiellement sur les côtes bretonnes et normandes, où elle est récoltée à marée basse. La laitue de mer peut être consommée crue, en salade, ou bien cuisinée dans différents plats tels que les soupes, les omelettes ou les gratins, Elle est également utilisée dans la préparation de produits transformés.
C'est une algue alimentaire très appréciée pour sa saveur iodée et ses nombreuses qualités nutritionnelles..
La Dulse
La Dulse (Palmaria palmata) est une algue rouge comestible que l'on trouve principalement dans les eaux froides de l'hémisphère nord, y compris en France. On peut trouver de la dulse sur certaines côtes bretonnes, plus précisément dans le Finistère sud.
La dulse est récoltée à marée basse, généralement à la main, en grappes attachées aux rochers. Elle est souvent utilisée dans la cuisine pour ses saveurs salées et légèrement fumées. On peut la consommer crue, séchée, ou utilisée comme ingrédient dans des plats cuisinés tels que les soupes, les salades ou les plats de fruits de mer, ou même des pizzas.
La dulse est riche en nutriments, tels que les vitamines A, B, C et E, ainsi que les minéraux tels que le fer, le potassium et le magnésium. Elle est également une source importante de protéines et de fibres.
Il est important de noter que la récolte de dulse doit se faire de manière durable et responsable, en respectant les écosystèmes marins. Il est conseillé de se renseigner auprès d'associations locales ou de professionnels de la pêche pour connaître les zones de récolte autorisées.
Le Wakamé
Le wakamé (Alaria esculenta) est une algue brune originaire d'Asie, principalement du Japon. Cependant, on peut également trouver du wakamé en France. En effet, il existe des fermes algicoles en Bretagne qui cultivent cette algue. =
Le wakamé est apprécié pour sa saveur iodée et son croquant. Il peut être consommé cru en salade, cuit dans des soupes, des plats sautés ou encore en accompagnement de poissons.
Il est important de noter que le wakamé est une algue qui pousse rapidement, et certaines espèces peuvent devenir envahissantes si elles sont introduites dans des milieux naturels. Il est préférable d'acheter du wakamé cultivé en France plutôt que de prélever des algues dans la nature.Nouveau paragraphe
Le Kombu Royal
Le kombu royal, également connu sous le nom scientifique Saccharina latissima, est une algue brune que l'on trouve principalement dans les eaux froides de l'Atlantique Nord. En France, le kombu royal peut être trouvé le long des côtes de la Manche et de l'Atlantique, principalement en Bretagne.
En raison de ses propriétés gustatives et nutritionnelles, le Kombu royal est utilisé dans la cuisine française, notamment dans la préparation de bouillons, de soupes et de plats à base de fruits de mer. Il est également parfois utilisé comme ingrédient dans la fabrication de produits alimentaires transformés tels que les algues séchées ou les condiments.
Il convient de noter que la récolte des algues, y compris le Kombu royal, est réglementée en France pour préserver les écosystèmes marins et assurer une exploitation durable. Il est donc important de se conformer aux réglementations locales lors de la récolte de kombu royal.
Les algues : la principale source de vie sur la planète.
Nos producteurs préférés ont un savoir faire qui va prendre ses sources, autant dans la connaissance des anciens dans ce domaine, que dans les améliorations que peuvent apporter les connaissances actuelles, en termes de santé, de biologie ou de milieu marin.
Nos équipes ont une vraie connaissance de l’algue et de sa reproduction, ce qui fait la grande qualité de nos récoltes.
Nous bénéficions de zone Natura 2000 pour la culture, de ramassage humain dans des zones protégées. Il y a un vrai respect de l’environnement et de la protection des milieux marins.
Pour la déshydratation des algues, nous avons une des structures les plus importante de Bretagne, car là également nous souhaitons une qualité maximum pour nos clients, ainsi nos algues déshydratées avec les meilleurs moyens du domaine, à basse température, gardent toutes leurs qualités et leurs gouts.
C.Groos
#algues #nature #alguesdeculture #sustainable #ecology #ocean #brittany #lequotidienaunaturelshop

Quand récolter les algues marines en France
Il existe plusieurs variétés d'algues récoltées en France, notamment les algues brunes, rouges et vertes. Voici quelques exemples d'algues récoltées en France :
Les conditions métrologiques peuvent faire varier les paramètres, les changements climatiques ont une incidence, sur les volumes et le croissances des algues.
1. Le kombu royal (Saccharina latissima) : peut être récolté tout au long de l'année en Bretagne. Cependant, la période de récolte optimale se situe généralement pendant les mois d'automne et d'hiver, lorsque la teneur en nutriments est la plus élevée. Il est important de respecter les réglementations locales et de recueillir le Kombu royal de manière durable et respectueuse de l'environnement. Il est également recommandé de consulter les prévisions météorologiques et de surveiller les conditions de la mer avant de se lancer dans la récolte.
2. Le wakame (Undaria pinnatifida) Le wakamé peut être récolté en Bretagne à partir du mois de juin jusqu'au mois de septembre, lorsque les algues sont à leur apogée de croissance. Cependant, il est important de noter que la réglementation concernant la récolte d'algues peut varier en fonction des zones et des conditions spécifiques et locales , il est donc recommandé de consulter les autorités compétentes ou les associations locales pour connaître les règles en vigueur.
3. La dulse (Palmaria palmata) : La dulse peut être récoltée en Bretagne tout au long de l'année, mais la période idéale se situe généralement entre le printemps et l'automne, surtout l’automne. La dulse est une algue comestible qui pousse sur les rochers au niveau des marées hautes. Il est important de respecter les règles de récolte durables pour préserver cet écosystème fragile.
4. La laitue de mer (Ulva lactuca) : récoltée sur les côtes françaises tout au long de l'année. La période idéale pour récolter la laitue de mer en Bretagne est généralement de septembre à mai. Pendant cette période, la laitue de mer est à son stade de croissance maximale et offre un meilleur goût et une texture plus tendre. Cependant, il est important de respecter les réglementations locales en matière de pêche et de cueillette, et de vérifier les conditions spécifiques liées à chaque site de récolte. Il est également recommandé de ne pas prélever plus que ce dont on a besoin et de préserver l'environnement marin.
5. Le nori (Porphyra spp.) : principalement sur les côtes atlantiques est généralement récolté en Bretagne entre les mois de mai et septembre. Cependant, la période exacte peut varier en fonction des conditions météorologiques et des caractéristiques spécifiques de la zone de récolte. Il est conseillé de se renseigner auprès des autorités compétentes ou des professionnels locaux pour connaître les dates précises de la récolte du nori dans la région de Bretagne. Par ailleurs le volume de récolte de Norie est faible en France.
6. Les haricots de mer ou spaghetti de mer (Himanthalia elongata.) sont des algues comestibles que l'on trouve généralement sur les côtes rocheuses et sableuses.
La récolte de ces algues peut varier en fonction des régions et des saisons. En général, les haricots de mer peuvent être récoltés du printemps à l’automne. Les spaghetti de mer sont récoltés principalement à marée basse.
Il est important de respecter les règlements locaux en matière de récolte d'algues et de s'assurer que les zones ne sont pas protégées ou polluées. Il est également conseillé de se renseigner auprès des autorités locales ou des associations de protection de l'environnement pour connaître les périodes autorisées de récolte et les quantités permises.
Il est important de noter que la réglementation concernant la collecte des algues en France peut varier d'une région à l'autre. Il est donc recommandé de se renseigner auprès des autorités locales ou des organismes compétents avant de pratiquer la récolte d'algues. De plus, il est essentiel de respecter les quotas de collecte fixés et d'éviter les zones protégées afin de préserver l'équilibre écologique des écosystèmes marins.
Il y a des règles a respecter lorsqu’on ramasse des algues ; il est important, de ne pas arracher les pieds, juste couper la partie haute, afin de préserver les récoltes ultérieures.
Quelle quantité d’algues consommer par jour ?
Une question revient régulièrement lors des commandes de nos clients : quelle quantité consommer par jour . Au Japon la consommation est presque quotidienne, elle peut aller jusqu’à 9 KG d’algues fraiches par an.
La quantité d'algues à consommer par jour varie en fonction du type d'algue et des besoins individuels. En général, une consommation modérée de 1 à 2 cuillères à soupe d'algues séchées par jour est considérée comme sûre pour la plupart des personnes
L’algue, l’aliment traditionnel en Asie
« … Au Chili, sur le site de Monte Verde datant de plus de 12 000 ans, des traces fossilisées d’algues confirment leur utilisation par les populations. …-
sources Cahiers de Nutrition et de Diététique
« …Des textes japonais, datant de plus de 6000 ans, précisent l’utilisation des algues comme remèdes.
sources Cahiers de Nutrition et de Diététique
Pour le grammage des algues déshydratées, nous avons pensé que souvent nous n’avons pas, dans notre cuisine, de balance suffisamment sensible pour ces quantités, aussi nous vous donnons un dosage en cuillère à café,
- La dose quotidienne est d’une à deux cuillères à café par jour, d’algues déshydratées.
- La dose pour les algues fraiches, sachant qu’il faut dix kilos d’algues fraiches pour faire un kilo d’algues déshydratées, est de 20g a 60 g par jour et par personne
- Les taux d’iode de cuivre de zinc, minéraux vitamines oligo-éléments et antioxydants sont variables d’une algue a l’autre. L'iode étant principale raison de ces précautions; nous vous recommandons de varier les algues consommées (exactement le même raisonnement que nous pourrions faire pour des légumes du potager).
Si vous souhaitez faire descendre le taux d’iode, le blanchiment dans l’eau est un des moyens les plus simples.
« Le CEVA propose de blanchir les algues 45 secondes environ dans de l’eau de mer ou de l’eau douce pour lessiver 80% de l’iode (Marfaing et al,2013) » source le site du CEVA.
https://www.ceva-algues.com/document/faut-il-avoir-peur-de-liode-des-algues/
https://www.sciencedirect.com/science/article/abs/pii/S0007996017300792
https://www.anses.fr/fr/content/iode-pourquoi-et-comment-en-consommer
https://www.anses.fr/fr/system/files/NUT2017SA0086.pdf
Au sujet de nos algues traitées à la japonaise :
Dans notre onglet algues fraiches à la Japonaise, nous vous offrons la possibilité d’avoir des algues fraiches traitées à la manière traditionnelle japonaise, donc avoir un taux d’iode moins fort en gardant les qualités de l’algue, et une finesse de goût sublimée . Nous pouvons vous proposer de la même façon (en gros et demi-gros) des algues déshydratées traitées ou non à la japonaise.
N’hésitez pas a nous joindre par mail ou téléphone pour avoir des précisions, tous nos produits n’étant pas obligatoirement sur le site.
Les légumes de la mer, aux qualités universelles.
Les algues sont riches en vitamines, minéraux, oligoéléments, protéines et acides aminés divers principes actifs...
les algues marines sont peu grasses et contiennent beaucoup de fibres,
Leur utilisation est une grande ressource alimentaire ; elles sont également utilisées dans la composition de cosmétiques et des applications agricoles...
Elles sont représentatives de la 5ème saveur : l’Umami, et ont des propriétés d'exhausteur de goût.
Les applications sont nombreuses : alimentaires, industrielles, cosmétiques, sanitaires, agricoles...
Les algues déshydratées
Les algues séchées sont une source de nourriture très utilisée dans de nombreuses cultures à travers le monde. Elles sont riches en nutriments essentiels tels que les vitamines, les minéraux, les oligo-éléments et les antioxydants. Cependant, pour que les algues séchées conservent leurs qualités nutritives et gustatives, il est important de les déshydrater correctement.
Les systèmes de déshydratation modernes utilisent des techniques telles que la lyophilisation, la déshydratation par air chaud et la déshydratation sous vide pour retirer l'eau des algues sans altérer leurs qualités. Ces systèmes de déshydratation sont spécialement conçus pour que les algues conservent tous leurs bienfaits nutritifs. Lorsque les algues sont déshydratées correctement, elles peuvent être stockées pendant des mois sans se détériorer, ce qui permet aux consommateurs d'avoir accès à des algues de qualité tout au long de l'année.
Notre système de déshydratation basse température permet de conserver tous les bienfaits de nos algues. De ce fait, vous pouvez en profiter pour en intégrer dans votre alimentation quotidienne comme les salades, les soupes, les smoothies et dans vos différents plats préférés. L'ajout d'algues séchées dans votre alimentation peut aider à prévenir certaines carences nutritionnelles et à maintenir votre corps en bonne santé. N’attendez plus pour adopter un nouveau style alimentaire plus attentif à vos besoins.
Les algues marines dans l’agriculture :
Les algues marines sont devenues un sujet de recherche de plus en plus intéressant dans le domaine de l'agriculture. Ces plantes aquatiques offrent en effet de nombreux avantages potentiels pour améliorer la qualité des terres et des légumes.
Tout d'abord, les algues marines sont riches en nutriments essentiels pour les plantes, tels que l'azote, le phosphore et le potassium. Plusieurs études ont montré que l'utilisation d'extraits d'algues marines comme engrais peut augmenter la croissance et le rendement des cultures. Par exemple, une recherche publiée dans le Journal of Applied Phycology a révélé que l'ajout d'extraits d'algues brunes à des plants de tomates a entraîné une augmentation significative de la production de fruits.
En plus d'être une source de nutriments, les algues marines peuvent également améliorer la structure des sols. Leurs polysaccharides peuvent agir comme un liant naturel, favorisant la formation de agrégats du sol, ce qui conduit à une meilleure aération et à un drainage amélioré. Une étude menée par des chercheurs de l'Institut National de Recherche Agronomique en France a montré que l'ajout d'algues marines à des sols dégradés a amélioré leur structure et a permis une meilleure rétention en eau.
En outre, les algues marines peuvent jouer un rôle important dans la lutte contre les maladies et les ravageurs. Certaines espèces d'algues produisent des composés bio actifs qui agissent comme des agents antimicrobiens et antifongiques. Une étude publiée dans le journal Science of the Total Environmenta suggéré que l'utilisation d'extraits d'algues brunes peut réduire la croissance des agents pathogènes du sol, tels que le Fusarium (champignons nuisibles), qui peuvent nuire aux cultures.
Enfin, les algues peuvent également contribuer à la durabilité de l'agriculture en tant que source d'engrais naturels. Contrairement aux engrais chimiques conventionnels, les algues marines sont renouvelables et ne contiennent pas de substances nocives pour l'environnement. Leur utilisation peut donc aider à réduire l'impact négatif de l'agriculture sur les écosystèmes aquatiques et terrestres.
En synthèse, les algues marines offrent de nombreux avantages potentiels pour améliorer la qualité des terres et des légumes. Leurs propriétés nutritives, leur capacité à améliorer la structure des sols, leur potentiel entant qu'agents antimicrobiens et leur durabilité en font un engrais prometteur.
Une fois encore les algues prouvent leurs innombrables capacités qui peuvent nous servir a avoir une agriculture durable.

Un plan de filière national macroalgues
« …… depuis plusieurs mois, les représentants des professionnels des différentes filières de l’algue en Bretagne- (CRPMEM, SRPARB, CSAVM, CRC BS et BN) se sont rassemblés autour de la table, afin que puissent remonter les enjeux et besoins de leurs filière.s afin qu’à terme, ensemble, puisse être construit un plan de filière macroalgue national. Se sont joints aux professionnels quelques acteurs académiques (SBR, Agrocampus) et le centre technique national dédié aux algues (CEVA)……. »
Source : blog du CEVA
https://blog.ceva-algues.com/un-plan-de-filiere-national-macroalgues-en-construction/
Le kombu Royal
Au japon et en Chine le Kombu est dans l’alimentation quotidienne. C’est une laminaire très riche en Iode. Lorsque vous ajoutez cette algue lors de la cuisson, elle ne masque pas le gout des autres ingrédients, elle est même reconnue comme un exhausteur de gout.
On peut l’utiliser comme papillote pour le viande ou le poisson.
Un beau morceau de Kombu dans un potage ou un bouillon, tout en parfumant légèrement votre met, y ajoutera beaucoup d’éléments nutritifs ; (Très utilisé dans les bouillons de la cuisine japonaise).

Un livre intéressant « La Révolution des algues », donne les clés des multiples usages des algues marines alimentaires . Voici quelques extraits montrant l’importance de ces légumes de mer, qui risquent de modifier nos habitudes alimentaires de façon positive :
Les bénéfices sur notre santé :
« Les systèmes de défense et les composés actifs [que les algues ont développés depuis plus d’un milliard d’années] sont aussi innombrables que méconnus. Pourtant, il est déjà reconnu et admis que les algues possèdent des propriétés anticancéreuses, anti-inflammatoires, antivirales, analgésiques, immunomodulatrices, antibactériennes et antifongiques » (p.115).
Un aspect étonnant par rapport a la pollution plastique (et qui ouvre beaucoup d’espoirs) :
« Au rythme actuel, d’ici 2050, la masse des polymères dans l’océan devrait représenter 750 millions de tonnes, soit une quantité supérieure à celles des poissons » ( p.143)
[…] Les algues pourraient bientôt remplacer le plastique. Un enjeu phénoménal. […] Des technologies nouvelles permettent d’accélérer largement le processus [de la sédimentation des algues mortes tombées au fond des océans et qui ont créé du pétrole] afin d’obtenir un « bioplastique » plus sain, recyclable ou biodégradable et parfois même comestible ! » (p.145) .
Encore un aspect auquel on ne s’attend pas de prime abord :
« Par la photosynthèse, les algues absorbent le carbone afin de fabriquer leur biomasse. […] Elles pourraient représenter la seule solution naturelle à grande échelle afin de récupérer le carbone dans l’atmosphère et le renvoyer sous notre sol terrestre, là où il fut stocké pendant des millions d’années (p.85)
.
Source : https://www.sciencesetavenir.fr

Pour le Végétarien
Pour complémenter un régime végétarien, ou pour rééquilibrer une alimentation, il n’y a rien de mieux que les algues marines :
- D’une part parce qu’elles sont très riches en minéraux et vitamines,
- D’autre part parce qu elles sont riche en protéines, a concurrence de 20% en moyenne.
Sous forme sèches quelques pincées dans votre alimentation, permettent d’avoir a la fois
- des fibres
- des acides aminés,
- des oligoéléments,
- des antioxydants
- et des protéines.
Sous forme fraiches, il faut commencer par les dessaler, puis les ajouter a vos plats.

Wakame ou undaria pinnatifida
Texte provenant d’un texte de Hèléne Marfaing du Ceva
« Undaria pinnatifida est une algue brune Laminariales, appartenant à la famille des Alariacées. En raison de son utilisation alimentaire ancestrale au Japon sous le nom de Wakamé,
……..
L’algue, possède une fronde brun verdâtre, translucide, en forme de triangle avec une nervure centrale caractéristique assez épaisse. Les individus âgés sont caractérisés une base crénelée (partie reproductrice appelée sporophylle), une nervure centrale et une fronde découpée en lanière, perpendiculaire à la nervure centrale.
Blanchie ou conservée au sel, l’algue devient d’une belle couleur verte stable dans le temps. L’odeur est très marine, typique de l’algue, ainsi que le goût. L’utilisation crue est facile dans des salades composées en variant les textures si l’on sépare lame et nervure centrale. La lame souple est très agréable dans des marinades au citron et garde une certaine mâche en bouche.
La nervure est assez dure mais facilement éminçable, assez jolie, en forme de lèvre et assez plaisante en bouche, croquante, juteuse, type cornichon (avec du vinaigre). Ce croquant de la nervure peut également être mis à profit dans des salades de crudités, avec des nervures taillées en julienne et assaisonnées au sésame (selon la fameuse salade de wakame que l’on trouve dans les sushis shops).
Poêlée, suée au beurre, l’algue devient fondante avec un bon goût beurré. Le résultat sué à l’huile est moins probant avec une texture qui devient dure, un goût herbacé et presque animal moins agréable.
Les bonnes associations pour le wakame se retrouvent avec les ingrédients suivants : citron, échalote, sésame, lentille et œufs.
Enfin comme l’Alaria, le wakame est une algue brune qui nécessite une cuisson assez longue pour attendrir sa texture. Selon le degré de cuisson, elles peuvent être légèrement croquantes ou fondantes et peuvent être intégrées en tant que garniture ou accompagnement dans :
Une poêlée de légumes
Une quiche
Une fondue ou compotée
Un bouillon
En poussant la cuisson et en mixant, elles apportent de la liaison pour la réalisation de :
Purées
Potages
Tartinables
Au-delà de la texture, le wakame apporte de la rondeur et de la profondeur aromatique caractéristique de l’algue et agit comme un exhausteur de goût. »
Source : Texte de Hèléne Marfaing Sensalg
De quoi se composent les algues marines ?
Mieux qu'un long discours : ce résumé, vous donnera une idée de la richesse exceptionnelle et des bienfaits naturels des algues marines (dans chaque description, pour chacune de nos algues, une fiche du CEVA, vous donnes des évaluations moyennes, pour 100 grammes d'algues séchées. cf "algues fraiches") Ci-dessous, un résumé qui n'est pas exhaustif, puisque chaque algue peut avoir des spécificités ; qu’elles soient consommées crues ou cuites elles développent des saveurs différentes et ce fameux umami (goût savoureux) typique, et cependant non invasif de ces légumes de la mer.
6 algues marines :
- KOMBU ROYAL
- LAITUE DE MER
- WAKAMÉ
- SPAGUETTI DE MER (HARICOT DE MER)
- DULSE
- NORI

L'algue alimentaire marine : un concentré d’éléments nutritifs pour votre corps, provenant de l’Océan
Les algues fraiches, ou déshydratées, vous procurent tout ce dont votre corps a besoin quotidiennement :
Elles sont peu caloriques, et vous donnent énergie et équilibre alimentaire.
contiennent :
- des vitamines A, B, D, E
- des minéraux tels que du zinc, du cuivre, du phosphore, fer
- du magnésium, du potassium, du calcium, du manganèse (oligo éléments)
- des glucides,
- de l’Iode,
- des protéines,
- des fibres .
Chaque algue contient ces éléments de façon variable.
- Les algues marine alimentaires, ont l’avantage de pouvoir agir également comme coupe faim,
- Elles peuvent aussi, être un accélérateur du transit.
- Les femmes enceintes devront éviter les algues les plus riches en iode telles que le Kombu ou le Haricot de mer.
L’algue est-elle une source de vitamine B12 ?
La B12 des algues est souvent considérée comme non assimilée par l’organisme. Cependant des recherches ont démontré que l’algue Nori contiendrait des quantités non négligeables de vitamine B12 active. Des expériences ont été faites avec des rats ayant un manque de vitamine B12, auxquels on a donné une alimentation enrichie d’algue Nori pendant une vingtaine de jours, ce qui a donné des résultats positifs : il y a eu une augmentation sensible du taux de vitamine B12 dans leur foie.
Soupe à l'oignon parfumée a l’algue Dulse,
croûtons au vieux comté
Soupe à l'oignon parfumée a l’algue Dulse,
croûtons au vieux comté
Ingrédients
• . 10 oignons des Cévennes
• . 2 cuillère(s) à soupe d'algues Dulse hachées
• . 120 g de vieux comté
• . 100 g de beurre
• . 2 bouillons cubes de bœuf
• . 4 morceaux de baguette
Préparation
1.Dans une casserole, faites fondre le beurre, ajoutez les oignons taillés finement, du sel, du poivre et faites cuire 30 mn pour obtenir une légère coloration brune.
2.Mouillez à hauteur d'eau, ajoutez les bouillons-cubes et laissez cuire doucement 1 h (ajoutez de l'eau si nécessaire).
3.Versez la soupe dans 4 bols, déposez les algues Dulse et quelques morceaux de vieux comté taillés joliment sur le dessus.
4.Sur chaque morceau de pain, parsemez un peu de comté haché et passez sous le gril du four à th. 6/180° pendant 3 à 5 mn.
5.Servez avec la soupe.
Réalisation Sandrine Giacobetti
Source : https://www.elle.fr
Elle à table
Exposition à l'Aquarium Tropical de la Porte Dorée à Paris.
Algues marines
Du 5 octobre 2021 au 4 septembre 2022
Alimentation, engrais, cosmétique, santé... les algues sont présentes dans notre quotidien et ce depuis des millénaires. Pourtant elles restent méconnues. Avec cette exposition, l’Aquarium tropical lève le voile sur le monde des grandes algues marines, leurs surprenantes propriétés, leur incroyable diversité et leur rôle primordial pour le maintien de la biodiversité.



